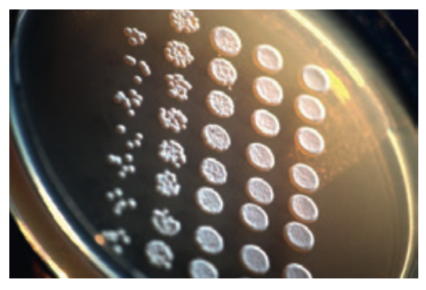

Мы приняли вашу заявку, свяжемся с вами в ближайшее время.

История
Часть товаров из корзины будет перемещена в статус отложенных и не сможет быть оформлена для заказа, если вы продолжите работу в данном регионе
История

История
История

|
Выделение и очистка нуклеиновых кислот на спин-колонках — наборы diaGene |
Экстра-миксы и наборы для ПЦР, diaGene
|
|
Ферменты для синтеза и модификации нуклеиновых кислот, diaGene
|
|
Трифосфаты
|
|
ДНК-маркеры diaGene
|
|
Репликаторы diaGene
|
|
Магнитные штативы
|
|
Агарозы
|
|
Среды для молекулярной биологии
|
|
Компоненты питательных сред
|
|
|
Некоторые реактивы для молекулярной биологии |
Наборы для выделения и очистки нуклеиновых кислот на спин-колонках и магнитных частицах В наборах diaGene используется свойство нуклеиновых кислот (НК) связываться с диоксидом кремния в присутствии хаотропных агентов — одноатомных спиртов или солей гуанидина. При этом формируется солевой мостик из положительно заряженных групп между диоксидом кремния и цепочкой ДНК или РНК. Если молекулы диоксида прикреплены к жёсткой подложке — можно сорбировать на них НК из раствора, отмыть от примесей с помощью смеси спирта и солевого раствора, а затем элюировать чистый препарат водой или буфером с низкой ионной силой. В качестве подложки, на которой находятся молекулы диоксида кремния, в наборах diaGene используются мембраны спин-колонок или магнитные частицы. Спин-колонки удобны для выделения НК вручную при небольшом потоке образцов (до 25 в день), когда требуется максимальный выход и чистота препарата. Магнитные частицы удобны при больших потоках образцов (до нескольких сотен в день), так как дают возможность автоматизации процесса выделения. |
Наборы diaGene на спин-колонках Стоимость одного выделения — от 34 руб. Наборы diaGene на спин-колонках предназначены для выделения ДНК и РНК из различных биологических образцов: бактериальных и животных клеток, цельной крови, плазмы и буккального эпителия, растений, пищевых продуктов, сперматозоидов, слюны, FFPE-препаратов, сухих пятен крови, животных тканей; для очистки фрагментов ДНК после ПЦР и других ферментативных реакций или для экстракции ДНК после разделения фрагментов в агарозном геле. Емкость спин-колонки – 25 мг нуклеиновой кислоты. Полученные препараты НК обладают высокой степенью чистоты, при этом количество и качество ДНК или РНК сопоставимо с таковыми при использовании аналогичных наборов зарубежных производителей, а себестоимость выделения ниже. Все протоколы просты без фенол-хлороформной экстракции и переосаждения спиртом. В составе наборов есть все необходимые буферы, спин-колонки, специальные пробирки для сбора фильтрата при центрифугировании. |
|
diaGene, Россия
Набор для выделения геномной ДНК из бактериальных клеток |
||||||||||||
|
3318.0050
|
||||||||||||
|
Набор предназначен для выделения геномной ДНК из бактериальных культур. Выделение ДНК начинается с лизиса бактериальных клеток в присутствии РНКазы и протеиназы К. Затем лизат наносится на спин-колонку diaGene с силикагелевым сорбентом. Очистка ДНК на спин-колонках начинается с избирательного связывания ДНК с сорбентом в присутствии хаотропной соли с последующей отмывкой связанной ДНК от примесей и заканчивается элюцией чистого препарата ДНК.
Сорбент позволяет выделять до 20 мкг свободной от примесей ДНК длиной 5-50 тысяч пар нуклеотидов. Набор diaGene для выделения геномной ДНК из бактериальных клеток, инструкция по применению, Диаэм, русск., 2 стр. |
||||||||||||
|
3498.0050
|
||||||||||||
|
Набор предназначен для выделения ДНК из гистологических препаратов, фиксированных в формалине и залитых парафином. Выделение ДНК начинается с растворения и удаления парафина. Затем образцы лизируются в присутствии протеиназы К, и лизат наносится на спин-колонку. ДНК избирательно связывается с фильтром колонки в присутствии хаотропной соли. Связанная ДНК отмывается от примесей и элюируется в виде чистого препарата, пригодного для большинства молекулярно-биологических манипуляций, например, ПЦР.
|
||||||||||||
|
3488.0050
|
||||||||||||
|
Набор предназначен для выделения геномной ДНК из образцов животных тканей массой от 20 до 100 мкг. Очистка ДНК происходит за счёт её связывания с сорбентом колонок diaGene. Связанная ДНК отмывается от примесей и элюируется в виде чистого препарата. Выход ДНК зависит от типа ткани и может составлять до 10 мкг.
|
||||||||||||
|
diaGene, Россия
Набор для выделения ДНК из культур клеток |
||||||||||||
|
3319.0050
|
||||||||||||
|
Набор предназначен для выделения ДНК из культур животных клеток. Выделение ДНК начинается с лизиса клеток, очистка нуклеиновой кислоты происходит за счёт связывания ДНК с сорбентом колонок diaGene. Связанная ДНК отмывается от примесей и элюируется в виде чистого препарата. Выход ДНК зависит от типа и количества клеток, поэтому надо учитывать, что ёмкость колонок — до 20 мкг нуклеиновой кислоты.
Набор diaGene для выделения ДНК из культур клеток, инструкция по применению, Диаэм, русск., 2 стр. |
||||||||||||
|
diaGene, Россия
Набор для выделения ДНК из пищевых продуктов и сырья, diaGene |
||||||||||||
|
3320.0250
|
|
250 выделений
|
|
37 298, руб.
37 298, руб. RUB
|
|
|
|
|||||
|
Выделение ДНК из пищевых продуктов и сырья начинается с гомогенизации образцов. Гомогенизацию можно проводить как вручную, так и с помощью автоматических мельниц или гомогенизаторов. Гомогенат инкубируется с протеиназой К и освобождается от большей части углеводов. Затем происходит очистка ДНК на спин-колонках. ДНК избирательно связывается с фильтром колонки в присутствии хаотропной соли. Связанная ДНК отмывается от примесей и элюируется в виде чистого препарата, пригодного для большинства молекулярно-биологических манипуляций, например, ПЦР.
Сорбент позволяет выделять до 25 мкг свободной от примесей ДНК. Набор diaGene для выделения ДНК из пищевых продуктов и сырья, инструкция по применению, Диаэм, русск., 4 стр. |
||||||||||||
|
diaGene, Россия
Набор для выделения ДНК из плазмы крови, diaGene |
||||||||||||
|
3321.0050
|
||||||||||||
|
Очистка ДНК на спин-колонках diaGene начинается с избирательного связывания ДНК с сорбентом в присутствии хаотропной соли с последующей отмывкой связанной ДНК от примесей и заканчивается элюцией чистого препарата ДНК.
Сорбент позволяет выделять до 25 мкг свободной от примесей ДНК. Растворы, входящие в состав наборов, обеспечивают высокий выход и чистоту конечного препарата ДНК. Набор diaGene для выделения ДНК из плазмы крови, инструкция по применению, Диаэм, русск., 2 стр. |
||||||||||||
|
diaGene, Россия
Набор для выделения ДНК из растительной ткани, diaGene |
||||||||||||
|
3352.0050
|
||||||||||||
|
Наборы предназначены для выделения геномной ДНК из зелёных частей растений. Параллельно с геномной ДНК растения происходит выделение геномной бактериальной и вирусной ДНК, что удобно при анализе инфицированности растения.
Очистка ДНК на микроколонках diaGene начинается с избирательного связывания ДНК с сорбентом в присутствии хаотропной соли с последующей отмывкой связанной ДНК от примесей и заканчивается элюцией чистого препарата ДНК. Сорбент позволяет выделять до 15 мкг геномной ДНК. Все реагенты хранятся при комнатной температуре (+15-25 °С). Набор diaGene для выделения ДНК из растительной ткани, Диаэм, русск., 4 стр.pdf |
||||||||||||
|
diaGene, Россия
Набор для выделения ДНК из слюны, спин-колонки |
||||||||||||
|
3403.0050
|
||||||||||||
|
Набор предназначен для выделения ДНК из слюны. Очистка ДНК происходит за счёт её связывания с сорбентом колонок diaGene. Связанная ДНК отмывается от примесей и элюируется в виде чистого препарата, пригодного для большинства молекулярно-биологических манипуляций, например, ПЦР. |
||||||||||||
|
3322.0050
|
||||||||||||
|
Данный комплект разработан для извлечения ДНК из клеток буккального эпителия. Процесс выделения основан на способности ДНК адсорбироваться на специальной колонке в среде с хаотропными солями. После связывания ДНК происходит удаление загрязнений с колонки, и в завершение чистая ДНК высвобождается в виде элюата. Количество полученной ДНК определяется объемом и состоянием исходного материала, а также условиями его хранения. Предельный выход ДНК составляет 20 мкг. Обычно длина выделенной ДНК варьируется в пределах 10-15 тысяч пар оснований, но может достигать 50-70 тысяч пар оснований. |
||||||||||||
|
diaGene, Россия
Набор для выделения ДНК из сперматозоидов, спин-колонки, diaGene |
||||||||||||
|
3367.0050
|
||||||||||||
|
Набор предназначен для выделения геномной ДНК из сперматозоидов. Очистка ДНК происходит за счёт её связывания с сорбентом колонок diaGene. Связанная ДНК отмывается от примесей и элюируется в виде чистого препарата, пригодного для большинства молекулярно-биологических манипуляций, например, ПЦР. Все реагенты, кроме раствора Протеиназы К, могут храниться при комнатной температуре. Раствор Протеиназы К необходимо хранить при -20 °С. |
||||||||||||
|
3497.0050
|
||||||||||||
|
Набор предназначен для выделения ДНК из сухих пятен крови на FTA-картах, на бумаге и некоторых видах ткани (хлопчатобумажная и шерстяная).
Пятна крови обрабатываются буфером с протеиназой К, полученный лизат наносится на спин-колонку. Очистка ДНК на спин-колонках diaGene происходит за счёт избирательного связывания ДНК с сорбентом в присутствии хаотропной соли с последующей отмывкой связанной ДНК от примесей. С колонки элюируется чистый препарат ДНК. Ёмкость колонки составляет до 25 мкг ДНК, но в конечном итоге зависит от количества примесей в наносимом на колонку лизате. |
||||||||||||
|
diaGene, Россия
Набор для выделения ДНК из цельной крови, diaGene |
||||||||||||
|
3361.0050
|
||||||||||||
|
Методика рассчитана на выделение ДНК из 100 мкл цельной крови, стабилизированной ЭДТА. Объём образца может варьировать от 50 до 200 мкл. При этом объёмы Буфера LBB, Протеиназы К и Раствора для сорбции должны быть изменены пропорционально.
Набор для выделения ДНК из цельной крови, diaGene, инструкция по применению, Диаэм, русск., 2 стр. |
||||||||||||
|
3489.0050
|
||||||||||||
|
Набор предназначен для выделения геномной ДНК из широкого спектра биологических образцов животного происхождения. Очистка ДНК происходит за счёт связывания нуклеиновой кислоты с сорбентом колонок diaGene. Связанная ДНК отмывается от примесей и элюируется в виде чистого препарата. Выход ДНК зависит от типа биологического материала; ёмкость сорбента составляет до 25 мкг.
Полученные образцы готовы для постановки ПЦР, секвенирования, рестрикции, лигирования и прочих реакций. Образцы могут быть использованы либо немедленно, либо в течение месяца при хранении на -20 °С. Для длительного хранения рекомендуется поместить образцы ДНК на -86 °С или добавить к ним 3 объёма 96% этанола и хранить при -20 °С. Данный набор предназначен для выделения геномной ДНК из:
|
||||||||||||
|
diaGene, Россия
Набор для выделения плазмидной ДНК из бактерий |
||||||||||||
|
3316.0050
|
||||||||||||
|
Набор предназначен для выделения до 25 мкг плазмидной ДНК длиной до 20 т.п.н. из 3-5 мл бактериальной культуры. Очистка ДНК на колонках diaGene происходит за счёт избирательного связывания ДНК с сорбентом в присутствии хаотропной соли с последующей отмывкой связанной ДНК от примесей и заканчивается элюцией чистого препарата ДНК.
Выход ДНК зависит от ряда факторов: копийности плазмиды, условий роста, объёма культуры и т.д. Не рекомендуется использовать для выделения плазмид длиной свыше 50 тысяч пар нуклеотидов, а также для получения препарата плазмидной ДНК для трансфекции эукариотических клеток. Набор diaGene для выделения плазмидной ДНК из бактерий, diaGene, инструкция по применению, Диаэм, русск., 2 стр. |
||||||||||||
|
diaGene, Россия
Набор для выделения РНК из культур клеток, diaGene |
||||||||||||
|
3317.0050
|
||||||||||||
|
Набор предназначен для выделения тотальной РНК из культуры животных клеток. Выделение РНК начинается с лизиса клеток, при этом ядра, содержащие геномную ДНК, остаются интактными. Очистка нуклеиновой кислоты происходит за счёт связывания РНК с сорбентом колонок diaGene. Связанная РНК отмывается от примесей и элюируется в виде чистого препарата. Выход РНК зависит от типа и количества клеток, поэтому надо учитывать, что ёмкость колонок — до 20 мкг.
Набор diaGene для выделения РНК из культур клеток, Диаэм, русск., 4 стр. |
||||||||||||
|
diaGene, Россия
Набор для выделения РНК из плазмы крови |
||||||||||||
|
3324.0050
|
||||||||||||
|
Набор предназначен для выделения РНК из плазмы крови. Полученные образцы РНК готовы для постановки ОТ-ПЦР и других реакций. Образцы могут быть использованы немедленно или в течение года после переосаждения РНК этанолом и хранения при -20 °С или -70 °С.
Набор diaGene для выделения РНК из плазмы крови, инструкция по применению, Диаэм, русск., 2 стр. |
||||||||||||
|
3490.0050
|
||||||||||||
|
Набор предназначен для очистки ДНК из реакционных смесей: после ПЦР, лигирования, рестрикции и т.д. Очистка ДНК происходит за счёт избирательного связывания с сорбентом колонок diaGene.
Буферы Y и Z содержат в своем составе индикатор кислотности. При оптимальном для сорбции рН индикатор имеет желтый цвет. Если после добавления к образцу буферов, цвет индикатора отличается от желтого, к смеси необходимо добавить 10 мкл 3М ацетата Na (pH 5.0). Буфер Y предназначен для очистки ДНК от низкомолекулярных примесей - солей и нуклеотидтрифосфатов. Буфер Z предназначен для удаления из образца не только низкомолекулярных соединений, но и коротких фрагментов ДНК (до 100 нуклеотидов), например, ПЦР-праймеров. |
||||||||||||
|
diaGene, Россия
Набор для очистки ДНК из реакционных смесей, diaGene |
||||||||||||
|
3325.0050
|
||||||||||||
|
Набор предназначен для очистки ДНК из реакционных смесей после ПЦР, лигирования, рестрикции и т.д. Очистка ДНК происходит за счёт избирательного связывания с сорбентом колонок на основе диоксида кремния. Фрагменты двцхцепочечной ДНК длиной свыше 50 п.н. сорбируются на мембрану колонки в присутствии хаотропного агента, а примеси (нуклеотидтрифосфаты, одноцепочечные олигонуклеотиды, соли и т.д.) оказываются в проскоке. Чистая ДНК элюируется буфером или деионизованной водой.
Ёмкость колонки составляет до 25 мкг ДНК, но зависит от состава наносимого на колонку препарата и от длины фрагментов ДНК. Буфер Y содержит в своем составе индикатор кислотности. Эффективность сорбции ДНК зависит от рН (связывание ДНК с сорбентом происходит при рН < 7.5). При оптимальном для сорбции рН индикатор имеет желтый цвет. Если после добавления к образцу Буфера Y, цвет индикатора отличается от желтого, к смеси необходимо добавить 10 мкл 3М ацетата Na (pH 5.0). Набор для очистки ДНК из реакционных смесей, diaGene, инструкция по применению, Диаэм, русск., 2 стр. |
||||||||||||
|
diaGene, Россия
Набор для элюции ДНК из агарозного геля, diaGene |
||||||||||||
|
3326.0050
|
||||||||||||
|
Набор предназначен для элюции и очистки фрагментов ДНК из легкоплавкого агарозного геля после электрофоретического разделения. С помощью набора можно элюировать ДНК из ТАЕ- или ТВЕ-геля, процесс прост и занимает не более 15-20 минут. После отмывки от примесей чистый препарат ДНК элюируется с колонки.
Полученный препарат ДНК может использоваться для рестриктазного расщепления, лигирования, секвенирования и др. Ёмкость колонки diaGene составляет до 25 мкг ДНК. Буфер для сорбции М содержит в своем составе индикатор кислотности. Эффективность сорбции ДНК зависит от рН (связывание ДНК с сорбентом происходит при рН < 7,5). При оптимальном для сорбции рН индикатор имеет желтый цвет. Если после добавления к образцу
буфера М цвет индикатора отличается от желтого, к смеси необходимо добавить 10 мкл 3М ацетата Na (pH 5,0).
Набор для элюции ДНК из агарозного геля, diaGene, инструкция по применению, Диаэм, русск., 2 стр. |
||||||||||||
|
diaGene, Россия
Спин-колонки для выделения нуклеиновых кислот, diaGene |
||||||||||||
|
3435.0050
|
||||||||||||
|
|
||||||||||||
Наборы diaGene на магнитных частицах В основе наборов на магнитных частицах лежит тот же принцип взаимодействия НК с диоксидом кремния в присутствии хаотропного агента, только диоксид кремния нанесён не на фильтр колонки, а на поверхность металлических частиц. Наборы на основе магнитных частиц удобны при одновременном выделении НК из большого количества образцов (до 96). Наборы diaGene на магнитных частицах предлагаются в двух форматах — на 96 или 384 выделения, могут быть использованы для выделения ДНК и РНК как вручную, так и с автоматическими станциями KingFisher, Thermo. |
|
3365.096
|
|||||||||||||||||||||||
|
Силикатный магносорбент для выделения ДНК/РНК на магнитном штативе (сепараторе), предназначен для выделения из зеленых частей растений и растительного сока. Состав: суспензия микрогранул силикагеля, содержащих парамагнитные нанокристаллы магнетита /маггемита, в солевом растворе (0,5 М NaCl, 0,05 % NaN₃).
|
|||||||||||||||||||||||
|
3366.096
|
|||||||||||||||||||||||
|
Силикатный магносорбент для выделения ДНК/РНК на магнитном штативе (сепараторе), предназначен для выделения из зеленых частей растений, коры, корней и сухих растений. Состав: суспензия микрогранул силикагеля, содержащих парамагнитные нанокристаллы магнетита /маггемита, в солевом растворе (0,5 М NaCl, 0,05 % NaN₃).
|
|||||||||||||||||||||||
|
diaGene, Россия
Магнитный силикагель 5%, diaGene |
|||||||||||||||||||||||
|
3499.0020
|
|
20 мл
|
|
13 500, руб.
13 500, руб. RUB
|
|
|
|
||||||||||||||||
|
Силикатный магносорбент для выделения ДНК/РНК на магнитном штативе (сепараторе). Состав: суспензия микрогранул силикагеля, содержащих парамагнитные нанокристаллы магнетита /маггемита, в солевом растворе (0,5 М NaCl, 0,05 % NaN₃).
|
|||||||||||||||||||||||
|
|
|||||||||||||||||||||||
Экстра-миксы и наборы для ПЦР, diaGeneЭкстра-миксы diaGene — это готовые 2х смеси для ПЦР; содержат в одной пробирке все необходимые для постановки ПЦР компоненты (кроме матрицы и праймеров): термофильную ДНК-полимеразу, буфер, dNTP. В состав некоторых экстра-миксов входит инертный краситель, интеркалирующий краситель SYBR Green I, пассивный краситель ROX и т.д. Преимущество экстра-миксов diaGene:
Наборы для ПЦР diaGene — комплекты отдельных пробирок, содержащих необходимые компоненты для постановки ПЦР (кроме матрицы и праймеров): термофильную ДНК-полимеразу (Taq-полимеразу с «горячим стартом», Pfu-полимеразу), буфер для ПЦР, смесь dNTP и другие. В состав наборов могут быть включены несколько различных буферов, а также раствор Mg²⁺, которые обеспечивают повышение производительности и дают возможность подбора оптимальных условий для амплификации сложных и GC-богатых последовательностей. Набор для амплификации длинных фрагментов содержит смесь ДНК-полимераз — Taq и Pfu, что повышает точность синтеза ДНК. Для удобства анализа ПЦР-продуктов с помощью электрофореза в наборы может быть включён буфер для нанесения на гель. В состав набора для ОТ-ПЦР кроме буфера, Taq-полимеразы и трифосфатов, входят обратная транскриптаза и праймеры для синтеза кДНК — случайный и олиго(дТ). Экстра-миксы и наборы для проведения стандартной ПЦР с HS-TaqПЦР с “горячим” стартом, высокопроизводительная и обычная ПЦР с высокой воспроизводимостью, наработка ПЦР-продуктов для ТА-клонирования, ОТ-ПЦР. |
|
diaGene, Россия
Набор для ПЦР с Taq-полимеразой расширенный (3 ПЦР-буфера) |
|||||||||||||||||||||||||||||||||||
|
1959.0500
|
|
500 единиц
|
хранение -20°C
|
|
7 419, руб.
7 419, руб. RUB
|
|
|
|
|||||||||||||||||||||||||||
|
Набор реактивов для ПЦР с Taq-полимеразой Hot Start расширенный содержит рекомбинантную HS-Taq ДНК-полимеразу, три реакционных буфера (10× ПЦР буфер, 5× Green буфер и 5× GC буфер), а также другие компоненты, необходимые для проведения ПЦР (за исключением матрицы ДНК и праймеров).
HS-Taq ДНК-полимераза представляет собой рекомбинантную Taq ДНК-полимеразу, инактивированную специфическими моноклональными антителами. HS-Taq ДНК-полимераза неактивна при температуре до +70 °С. Это позволяет избежать образования неспецифических продуктов и праймер-димеров при низкой температуре на стадии смешивания компонентов ПЦР-смеси. Активация осуществляется на первом цикле ПЦР путём инкубации в течение 5 мин при +95 °С. Рекомбинантная Taq ДНК-полимераза обладает 5´-3´ ДНК-зависимой полимеразной активностью и 5’-3’ экзонуклеазной активностью нативной Taq ДНК-полимеразы из Thermus aquaticus. Скорость продвижения Taq ДНК-полимеразы зависит от сложности ДНК-матрицы и составляет примерно 1 т.п.н./мин. Рекомбинантная HS-Taq ДНК-полимераза идеально подходит для стандартной ПЦР с матрицы до 5 т.п.н.; она обладает способностью присоединять адениновый остаток к 3’-концу синтезируемой цепи, поэтому продукты ПЦР могут использоваться для ТА-клонирования. 10× ПЦР буфер оптимизирован для проведения большинства видов ПЦР, в том числе для проведения ПЦР в режиме реального времени с интеркалирующими красителями или флуоресцентными зондами. Буфер химически стабилен, инертен и не меняет оптимальной температуры отжига праймеров или характеристики плавления матрицы. 5× Green буфер содержит маркерные красители (сине-зелёный и желтый) и добавки, увеличивающие плотность раствора, для удобного нанесения на гель. Предназначен для стандартной ПЦР с оценкой выхода продуктов по конечной точке (методом разделения продуктов в геле). Буфер химически стабилен, инертен и не меняет оптимальной температуры отжига праймеров или характеристики плавления матрицы. 5× GC буфер предназначен для амплификации участков ДНК, богатых GC и/или имеющих сложную пространственную структуру. Буфер химически стабилен, содержит вещества, меняющие температуру отжига праймеров и характеристики плавления матрицы. В состав всех буферов входят добавки, повышающие время полужизни и процессивность Taq ДНК-полимеразы за счет повышения её стабильности во время ПЦР. Все буферы в условиях разбавления до 1× (однократного) содержат 1,5 мМ MgCl2. Входящие в набор 50 мМ раствор MgCl2 и 50× смесь dNTP позволяют легко оптимизировать реакционную смесь под конкретную систему "матрица-праймеры". 6× Буфер для нанесения на гель облегчает пробоподготовку для электрофореза ПЦР-продуктов и контроль над ходом электрофореза. Состав набора
* За единицу активности принимали количество фермента, катализирующее включение 10 нмоль dNTP в кислотонерастворимый продукт за 30 мин при 74 °С. Условия реакции:50 мМ Трис-HCl, pH 9.0 (при 25 °С), 50 мМ NaCl, 10 мМ MgCl2, 200 мM dATP, 200 мM dCTP, 200 мM dGTP, 50 мM [3H] dTTP, 0,25 мг/мл активированной ДНК из тимуса теленка. Буфер для хранения HS-Taq ДНК-полимеразы: 50 мМ Трис-HCl, pH 8.0 (при 25 °С), 50 мМ NaCl, 0.1 мМ ЭДТА, 1мМ дитиотреитол, 50% (v/v) глицерин и 1% (v/v) Тритон Х-100. 10× ПЦР буфер: 100 мM Трис-HCl, рН 8.5 (при 25 °С), 500 мM KCl, 15 мM MgCl2, 0.5% (v/v) Tween 20, стабилизаторы Taq ДНК-полимеразы. 5× Green буфер: 50 мM Трис-НCl, рН 8.5 (при 25 °С), 250 мM KCl, 7,5 мМ MgCl2, 0.5% (v/v) Tween 20, стабилизаторы Taq ДНК-полимеразы, маркерные красители. 5× GC буфер: 100 мM Трис-НCl, рН 8.5 (при 25 °С), 250 мM KCl, 7.5 мМ MgCl2, 0.5% (v/v) Tween 20, ДМСО, стабилизаторы Taq ДНК-полимеразы. Область применения:
Ингибиторы: ионные детергенты (дезоксихолат натрия, саркозил и додецилсульфат натрия (SDS) в концентрациях выше, чем 0,06, 0,02 и 0,01%, соответственно). Инактивируется экстракцией смесью фенол/хлороформ. Хранение и транспортировка: при -20 °С; не более 50 циклов замораживания-размораживания. Срок хранения: при соблюдении условий хранения и транспортировки 1 год. |
|||||||||||||||||||||||||||||||||||
|
diaGene, Россия
Экстра-микс для ПЦР HS-Taq PCR |
|||||||||||||||||||||||||||||||||||
|
1960.0200
|
|
200 реакций
|
транспортировка -20°C
|
|
6 666, руб.
6 666, руб. RUB
|
|
|
|
|||||||||||||||||||||||||||
|
Экстра-микс HS-Taq представляет собой 2-кратную реакционную смесь, содержащую все компоненты, необходимые для проведения ПЦР (исключая ДНК-матрицу и праймеры):
Экстра-микс HS-Taq не содержит веществ, мешающих проведению оптического контроля за ходом реакции по изменению флюоресценции пробы. HS-Taq ДНК-полимераза, входящая в состав экстра-микса, неактивна при температуре ниже +70оС. Для её активации необходим прогрев реакционной смеси при +95°С в течение 5 мин. Рекомбинантная HS-Taq ДНК-полимераза обладает 5´-3´ ДНК-зависимой полимеразной активностью и 5’-3’ экзонуклеазной активностью нативной Taq ДНК-полимеразы из Thermus aquaticus. Скорость продвижения Taq ДНК-полимеразы зависит от сложности ДНК-матрицы и составляет примерно 1 т.п.н./мин. Рекомбинантная HS-Taq ДНК-полимераза идеально подходит для стандартной ПЦР с матрицы до 5 т.п.н.; она обладает способностью присоединять адениновый остаток к 3’-концу синтезируемой цепи, поэтому продукты ПЦР могут использоваться для ТА-клонирования. Кроме экстра-микса, в состав набора также включены 50 мМ MgCl2 и стерильная вода. Входящий в набор раствор MgCl2 позволяет легко оптимизировать реакционную смесь под конкретную систему "матрица-праймеры". Состав набора
Состав экстра-микса HS-Taq (2х):
Ингибиторы: ионные детергенты (дезоксихолат натрия, саркозил и додецилсульфат натрия (SDS) в концентрациях выше, чем 0,06, 0,02 и 0,01%, соответственно). Инактивируется экстракцией смесью фенол/хлороформ. Срок хранения и транспортировка: 1 год при -20 °С; не более 50 циклов замораживания- размораживания. |
|||||||||||||||||||||||||||||||||||
|
diaGene, Россия
Экстра-микс для ПЦР HS-Taq PCR-Color |
|||||||||||||||||||||||||||||||||||
|
1961.0200
|
|
200 реакций
|
хранение -20°C, транспортировка -20°C
|
|
6 666, руб.
6 666, руб. RUB
|
|
|
|
|||||||||||||||||||||||||||
|
Экстра-микс HS-Taq Color представляет собой 2-кратную реакционную смесь, содержащую все компоненты, необходимые для проведения ПЦР (исключая ДНК-матрицу и праймеры):
Увеличивающие плотность пробы компоненты и красители позволяют наносить реакционную смесь сразу на гель после амплификации для удобства работы с ней. Форма реагентов для проведения ПЦР в виде экстра-микса экономит время и снижает вероятность контаминации за счет малого числа шагов пипетирования. HS-Taq ДНК-полимераза, входящая в состав экстра-микса, неактивна при температуре ниже +70оС. Для её активации необходим прогрев реакционной смеси при +95 °С в течение 5 мин. Рекомбинантная HS-Taq ДНК-полимераза обладает 5´-3´ ДНК-зависимой полимеразной активностью и 5’-3’ экзонуклеазной активностью нативной Taq ДНК-полимеразы из Thermus aquaticus. Скорость продвижения Taq ДНК-полимеразы зависит от сложности ДНК-матрицы и составляет примерно 1 т.п.н./мин. Рекомбинантная HS-Taq ДНК-полимераза идеально подходит для стандартной ПЦР с матрицы до 5 т.п.н.; она обладает способностью присоединять адениновый остаток к 3’-концу синтезируемой цепи, поэтому продукты ПЦР могут использоваться для ТА-клонирования. Кроме экстра-микса, в состав набора также включены 50 мМ MgCl2 и стерильная вода. Входящий в набор раствор MgCl2 позволяет легко оптимизировать реакционную смесь под конкретную систему "матрица-праймеры". Состав набора
Состав экстра-микса HS-Taq Color (2х):
Ингибиторы: ионные детергенты (дезоксихолат натрия, саркозил и додецилсульфат натрия (SDS) в концентрациях выше, чем 0,06, 0,02 и 0,01%, соответственно). Инактивируется экстракцией смесью фенол/хлороформ. Срок хранения и транспортировка: 1 год при -20 °С; не более 50 циклов замораживания-размораживания. |
|||||||||||||||||||||||||||||||||||
|
diaGene, Россия
Набор для ПЦР с Taq-полимеразой Hot Start |
|||||||||||||||||||||||||||||||||||
|
1957.0500
|
|
500 единиц
|
транспортировка -20°C
|
|
3 096, руб.
3 096, руб. RUB
|
|
|
|
|||||||||||||||||||||||||||
|
Набор реактивов для ПЦР с Taq-ДНК-полимеразой Hot Start содержит рекомбинантную HS-Taq ДНК-полимеразу и растворы всех необходимых компонентов для проведения стандартной ПЦР c "горячим" стартом (за исключением матрицы ДНК и праймеров). В состав набора входят: раствор HS-Taq ДНК-полимеразы (5 ед. акт./мкл), 5× ПЦР буфер, 50 мМ MgCl2, 50× смесь dNTP и 6× буфер для нанесения на гель. Все реагенты высокого качества и оптимизированы для проведения ПЦР.
HS-Taq ДНК-полимераза представляет собой рекомбинантную Taq ДНК-полимеразу, инактивированную специфическими моноклональными антителами. HS-Taq ДНК-полимераза неактивна при температуре до +70 °С. Это позволяет избежать образования неспецифических продуктов и праймер-димеров при низкой температуре на стадии смешивания компонентов ПЦР-смеси. Активация осуществляется на первом цикле ПЦР путём 5-минутной инкубации при +95 °С. Рекомбинантная Taq ДНК-полимераза обладает 5´-3´ ДНК-зависимой полимеразной активностью и 5´-3´ экзонуклеазной активностью нативной Taq ДНК-полимеразы из Thermus aquaticus. Скорость продвижения Taq ДНК-полимеразы зависит от сложности ДНК-матрицы и составляет примерно 1 т.п.н./мин. Рекомбинантная HS-Taq ДНК-полимераза идеально подходит для стандартной ПЦР с матрицы до 5 т.п.н. и обладает способностью присоединять адениновый остаток к 3’-концу синтезируемой цепи ДНК, поэтому ПЦР-фрагменты пригодны для ТА-клонирования. 5× ПЦР-буфер оптимизирован для проведения эффективной и воспроизводимой ПЦР (не содержит MgCl2). В состав буфера входят добавки, повышающие время полужизни и процессивность HS-Taq ДНК-полимеразы за счет повышения её стабильности во время ПЦР. Буфер химически стабилен, инертен и не меняет оптимальной температуры отжига праймеров или характеристики плавления матрицы. Входящие в набор 50 мМ раствор MgCl2 и 50× смесь dNTP позволяют легко оптимизировать реакционную смесь под конкретную систему «матрица-праймеры», а 6× Буфер для нанесения на гель облегчает пробоподготовку для электрофореза ПЦР-продуктов и контроль над ходом электрофореза. Состав набора
* За единицу активности принимали количество фермента, катализирующее включение 10 нмоль dNTP в кислотонерастворимый продукт за 30 мин при 74 °С.Условия реакции:50 мМ Трис-HCl, pH 9.0 (при 25 °С), 50 мМ NaCl, 10 мМ MgCl2, 200 мM dATP, 200 мM dCTP, 200 мM dGTP, 50 мM [3H] dTTP, 0.25 мг/мл активированной ДНК из тимуса теленка. Буфер для хранения HS-Taq ДНК-полимеразы: 50 мМ Трис-HCl, pH 8.0 (при 25 °С), 50 мМ NaCl, 0,1 мМ ЭДТА, 1мМ дитиотреитол, 50% (v/v) глицерин и 1% (v/v) Тритон Х-100. 5× ПЦР-буфер: 50 мM Трис-НCl, рН 8.5 (при 25 °С), 250 мM KCl, 0.5% (v/v) Tween 20, стабилизаторы Taq ДНК-полимеразы. Область применения:
Ингибиторы: ионные детергенты (дезоксихолат натрия, саркозил и додецилсульфат натрия (SDS) в концентрациях выше, чем 0,06, 0,02 и 0,01%, соответственно). Инактивируется экстракцией смесью фенол/хлороформ. Хранение и транспортировка: при -20°С; не более 50 циклов замораживания-размораживания. Срок хранения: при соблюдении условий хранения и транспортировки 1 год. |
|||||||||||||||||||||||||||||||||||
|
1958.0500
|
|
500 единиц
|
транспортировка -20°C
|
|
3 096, руб.
3 096, руб. RUB
|
|
|
|
|||||||||||||||||||||||||||
|
Набор реактивов для ПЦР с Taq-полимеразой Hot Start (+MgCl2) содержит рекомбинантную HS-Taq ДНК-полимеразу и растворы всех необходимых компонентов для проведения стандартной ПЦР c “горячим” стартом (за исключением матрицы ДНК и праймеров). ПЦР-буфер, входящий в состав набора, уже содержит MgCl2
в концентрации 10 мМ, достаточной для постановки большинства рутинных ПЦР.
HS-Taq ДНК-полимераза представляет собой рекомбинантную Taq ДНК-полимеразу, инактивированную специфическими моноклональными антителами. HS-Taq ДНК-полимераза не активна при температуре до +70 °С. Это позволяет избежать образования неспецифических продуктов и праймер-димеров при низкой температуре на стадии смешивания компонентов ПЦР-смеси. Активация осуществляется на первом цикле ПЦР путём инкубации в течение 5 мин при +95 °С. Рекомбинантная Taq ДНК-полимераза обладает 5´-3´ ДНК-зависимой полимеразной активностью и 5’-3’ экзонуклеазной активностью нативной Taq ДНК-полимеразы из Thermus aquaticus. Скорость продвижения Taq ДНК-полимеразы зависит от сложности ДНК-матрицы и составляет примерно 1 т.п.н./мин. HS-Taq ДНК-полимераза идеально подходит для стандартной ПЦР с матрицы до 5 т.п.н.; она обладает способностью присоединять адениновый остаток к 3’-концу синтезируемой цепи, поэтому продукты ПЦР могут использоваться для ТА-клонирования. 5× ПЦР-буфер (+MgCl2) оптимизирован для проведения эффективной и воспроизводимой ПЦР. В состав буфера входят MgCl2 (10 мМ) и добавки, повышающие время полужизни и процессивность HS-Taq ДНК-полимеразы за счет повышения её стабильности во время ПЦР. Буфер химически стабилен, инертен и не меняет оптимальной температуры отжига праймеров или характеристики плавления матрицы. Входящие в набор 50 мМ раствор MgCl2 и 50× смесь dNTP позволяют легко оптимизировать реакционную смесь под конкретную систему «матрица-праймеры», а 6× Буфер для нанесения на гель облегчает пробоподготовку для электрофореза ПЦР-продуктов и контроль над ходом электрофореза. Состав набора
* За единицу активности принимали количество фермента, катализирующее включение 10 нмоль dNTP в кислотонерастворимый продукт за 30 мин при 74 °С. Условия реакции: 50 мМ Трис-HCl, pH 9.0 (при 25 °С), 50 мМ NaCl, 10 мМ MgCl2, 200 мM dATP, 200 мM dCTP, 200 мM dGTP, 50 мM [3H] dTTP, 0,25 мг/мл активированной ДНК из тимуса теленка. Буфер для хранения HS-Taq ДНК-полимеразы: 50 мМ Трис-HCl, pH 8.0 (при 25 °С), 50 мМ NaCl, 0.1 мМ ЭДТА, 1мМ дитиотреитол, 50% (v/v) глицерин и 1% (v/v) Тритон Х-100. 5× ПЦР буфер (+MgCl2): 50 мM Трис-НCl, рН 8.5 (при 25 °С), 250 мM KCl, 10 мМ MgCl2, 0.5% (v/v) Tween 20, стабилизаторы Taq ДНК-полимеразы. Область применения: ПЦР с “горячим” стартом. Высокопроизводительная ПЦР. Обычная ПЦР с высокой воспроизводимостью. Наработка ПЦР-продуктов для ТА клонирования. Вторая стадия ОТ-ПЦР. Ограничения к использованию:
Ингибиторы: ионные детергенты (дезоксихолат натрия, саркозил и додецилсульфат натрия (SDS) в концентрациях выше, чем 0,06, 0,02 и 0,01%, соответственно). Инактивируется экстракцией смесью фенол/хлороформ. Хранение и транспортировка: при -20 °С; не более 50 циклов замораживания-размораживания. Срок хранения: при соблюдении условий хранения и транспортировки 1 год. |
|||||||||||||||||||||||||||||||||||
|
|
|||||||||||||||||||||||||||||||||||
|
diaGene, Россия
Экстра-микс для амплификации длинных фрагментов LR HS-Taq PCR |
||||||||||||
|
3327.0100
|
|
100 реакций
|
хранение -20°C
|
|
10 589, руб.
10 589, руб. RUB
|
|
|
|
||||
|
Применение: получение длинных фрагментов до 25 000 п.н., получение продуктов для ТА-клонирования, амплификация GC-богатых и сложных матриц. Из-за содержания инертного красителя смесь не рекомендуется использовать для ПЦР в реальном времени и других приложений, требующих измерения флуоресценции; для таких приложений необходимо использовать смесь qPCR (2х) и qPCR SYBR Blue (2х).
|
||||||||||||
|
|
||||||||||||
Из-за содержания инертного красителя смесь не рекомендуется использовать для ПЦР в реальном времени и других приложений, требующих измерения флуоресценции; для таких приложений использовать смесь qPCR (2х) и qPCR SYBR Blue (2х).Количественная ПЦР в реальном времени с детекцией продукта с помощью флуоресцентных зондов или интеркалирующего красителя SYBR Green IЭкстра-миксы diaGene — это готовые 2х смеси для ПЦР; содержат в одной пробирке все необходимые для постановки ПЦР компоненты (кроме матрицы и праймеров): термофильную ДНК-полимеразу, буфер, dNTP. Также доступны наборы на 2040 реакций. |
|
1972.0400
|
|
400 реакций
|
|
6 958, руб.
6 958, руб. RUB
|
|
|
|
|||||||||||||||||
|
Область применения: ПЦР в режиме реального времени с использованием интеркалирующего красителя SYBR Green I, обычная ПЦР, высоковоспроизводимая ПЦР, генотипирование; идеально подходит для амплификаторов, обеспечивающих нормализацию сигнала по пассивному референсному красителю ROX: Thermo Life Technologies (ABI) 7000, 7300, 7700, 7900, 7900HT, StepOne Plus. |
||||||||||||||||||||||||
|
1974.0400
|
|
400 реакций
|
хранение -20°C, транспортировка +4°C
|
|
6 958, руб.
6 958, руб. RUB
|
|
|
|
||||||||||||||||
|
Экстра-микс HS-qPCR SYBR Blue предназначен для проведения количественной ПЦР в режиме реального времени с использованием флуоресцентного красителя SYBR Green I и представляет собой 2-кратную реакционную смесь, содержащую все компоненты, необходимые для проведения ПЦР в режиме реального времени (исключая ДНК-матрицу и праймеры):
SYBR Green I - флуоресцентный интеркалирующий краситель для количественной и качественной детекции продуктов в ходе ПЦР в режиме реального времени. SYBR Green I обеспечивает простой и экономичный вариант для детекции и количественного определения ПЦР-продуктов без необходимости использования специфичных флуоресцентных зондов. В ходе амплификации краситель SYBR Green I встраивается в малую бороздку ДНК ПЦР-продуктов и испускает более сильный по сравнению с несвязанным красителем флуоресцентный сигнал. Максимумы поглощения и испускания SYBR Green I - 494 нм и 521 нм соответственно, что позволяет использовать его со всеми известными на сегодняшний день амплификаторами для проведения ПЦР в режиме реального времени. HS-Taq ДНК-полимераза, входящая в состав экстра-микса, неактивна при комнатной температуре. Для её активации необходим прогрев реакционной смеси при 95 °С в течение 5 мин. П Рекомбинантная HS-Taq ДНК-полимераза обладает 5´-3´ ДНК-зависимой полимеразной активностью и 5’-3’ экзонуклеазной активностью нативной Taq ДНК-полимеразы из Thermus aquaticus. Скорость продвижения Taq ДНК-полимеразы зависит от сложности ДНК-матрицы и составляет примерно 1 т.п.н./мин. Рекомбинантная HS-Taq ДНК-полимераза идеально подходит для стандартной ПЦР с матрицы до 5 т.п.н. Кроме экстра-микса, в состав набора также включены 50 мМ MgCl₂ и стерильная вода. Входящий в набор раствор MgCl₂ позволяет легко оптимизировать реакционную смесь под конкретную систему "матрица-праймеры". Форма реагентов для проведения ПЦР в виде экстра-микса экономит время и снижает вероятность контаминации за счет малого числа шагов пипетирования. Состав Экстра-микса HS-qPCR SYBR Blue:
Преимущества использования экстра-микса:
Не рекомендуется использовать для ПЦР в реальном времени с флуоресцентно-меченными зондами. Для таких приложений следует использовать Экстра-микс HS-qPCR (2×). Срок хранения и транспортировка: 1 год при -20 °С; не более 50 циклов замораживания-размораживания. |
||||||||||||||||||||||||
|
diaGene, Россия
Экстра-микс для ПЦР в реальном времени HS-qPCR 2х |
||||||||||||||||||||||||
|
3393.0400
|
|
400 реакций
|
транспортировка +2...+8 °C
|
|
6 715, руб.
6 715, руб. RUB
|
|
|
|
||||||||||||||||
|
Реакционная смесь, содержащая Taq ДНК-полимеразу с «горячим» стартом, для проведения ПЦР в режиме реального времени с флуоресцентными зондами.
Набор содержит реакционную смесь HS-qPCR (2×) и стерильную воду. Реакционная смесь HS-qPCR (2×) предназначена для проведения количественной ПЦР в режиме реального времени c использованием флуоресцентно-меченых зондов. В состав реакционной смеси HS-qPCR (2×) входят все необходимые компоненты ПЦР (исключая ДНК-матрицу, праймеры и зонд): HS-Taq ДНК-полимераза, смесь dNTP, 2×ПЦР-буфер, Mg²⁺. Область применения: ПЦР c “горячим” стартом в режиме реального времени с применением олигонуклеотидных зондов; обычная ПЦР; высоковоспроизводимая ПЦР; мультиплексная ПЦР; генотипирование. Хранение: в защищённом от света месте при +25 °С – 7 дней; при +4 °С – 4 месяца; при -20°С – 18 месяцев; не более 50 циклов замораживания-размораживания. Транспортировка: при 0 - +4 °С, допускается транспортировка при комнатной температуре до 3-х дней. |
||||||||||||||||||||||||
|
1976.0400
|
|
400 реакций
|
|
7 614, руб.
7 614, руб. RUB
|
|
|
|
|||||||||||||||||
|
1977.0400
|
|
400 реакций
|
|
7 614, руб.
7 614, руб. RUB
|
|
|
|
|||||||||||||||||
|
Область применения: ПЦР c “горячим” стартом в режиме реального времени с применением олигонуклеотидных зондов, обычная ПЦР, высоковоспроизводимая ПЦР, генотипирование; для амплификаторов, обеспечивающих нормализацию сигнала по пассивному референсному красителю ROX: Thermo Life Technologies (ABI) 7500, 7500. |
||||||||||||||||||||||||
|
1980.0400
|
|
400 реакций
|
|
6 715, руб.
6 715, руб. RUB
|
|
|
|
|||||||||||||||||
|
Область применения: ПЦР c “горячим” стартом в режиме реального времени с применением флуоресцентно-меченных зондов и нормировкой данных по сигналу ROX, обычная ПЦР, высоковоспроизводимая ПЦР, мультиплексная ПЦР, генотипирование. Смесь подходит для амплификаторов, обеспечивающих нормализацию сигнала по пассивному референсному красителю ROX: Thermo Life Technologies (ABI) 7000, 7300, 7700, 7900, 7900HT, StepOne Plus. |
||||||||||||||||||||||||
|
1981.0400
|
|
400 реакций
|
|
6 715, руб.
6 715, руб. RUB
|
|
|
|
|||||||||||||||||
|
Область применения: ПЦР c “горячим” стартом в режиме реального времени с применением флуоресцентно-меченных зондов и нормировкой данных по сигналу ROX, обычная ПЦР, высоковоспроизводимая ПЦР, мультиплексная ПЦР, генотипирование; для амплификаторов, обеспечивающих нормализацию сигнала по пассивному референсному красителю ROX: Thermo Life Technologies (ABI) 7500, 7500 Fast, ViiA 7, QuantStudio 12K; Stratagene Mx4000, Mx3005P, Mx3000P. |
||||||||||||||||||||||||
|
1983.0400
|
|
400 реакций
|
транспортировка +4°C
|
|
7 298, руб.
7 298, руб. RUB
|
|
|
|
||||||||||||||||
|
1984.0400
|
|
400 реакций
|
|
7 298, руб.
7 298, руб. RUB
|
|
|
|
|||||||||||||||||
|
Область применения: ПЦР c “горячим” стартом в режиме реального времени с применением флуоресцентно-меченных зондов и нормировкой данных по сигналу ROX, обычная ПЦР, высоковоспроизводимая ПЦР, мультиплексная ПЦР, генотипирование. Смесь подходит для амплификаторов, обеспечивающих нормализацию сигнала по пассивному референсному красителю ROX: Thermo Life Technologies (ABI) 7000, 7300, 7700, 7900, 7900HT, StepOne Plus. |
||||||||||||||||||||||||
|
1985.0400
|
|
400 реакций
|
хранение -20°C, транспортировка -20°C
|
|
7 298, руб.
7 298, руб. RUB
|
|
|
|
||||||||||||||||
|
Область применения: ПЦР c “горячим” стартом в режиме реального времени с применением флуоресцентно-меченных зондов и нормировкой данных по сигналу ROX, обычная ПЦР, высоковоспроизводимая ПЦР, мультиплексная ПЦР, генотипирование; для амплификаторов, обеспечивающих нормализацию сигнала по пассивному референсному красителю ROX: Thermo Life Technologies (ABI) 7500, 7500 Fast, ViiA 7, QuantStudio 12K; Stratagene Mx4000, Mx3005P, Mx3000P. |
||||||||||||||||||||||||
|
|
||||||||||||||||||||||||

|

|

|
|
diaGene, Россия
ДНК-полимераза Taq, термостабильная, высокопроцессивная |
||||||||||||
|
1919
|
|
1000 единиц
|
транспортировка -20°C
|
|
2 314, руб.
2 314, руб. RUB
|
|
|
|
||||
|
Рекомбинантная форма, выделенная из E. coli. Буфер хранения: 50 мМ Трис-HCl, pH 8,0 (при 25°С), 50 мМ NaCl, 0,1 мМ ЭДТА, 1 мМ дитиотрейтол, 50 % глицерин и 1 % Тритон Х-100. Определение единицы активности: За единицу активности принимали количество фермента, катализирующее включение 10 нмоль dNTP в кислотонерастворимый продукт за 30 мин при 74°С.Условия реакции: 50 мМ трис-HCl, pH 9,0 (при 25° С), 50 мМ NaCl, 10 мМ MgCl2, 200 мM dATP, 200 мM dCTP, 200 мM dGTP, 50 мM [3H] dTTP, 0,25 мг/мл активированной ДНК из тимуса теленка.
Хранение и транспортировка: -20°С. |
||||||||||||
|
diaGene, Россия
Урацил-ДНК-гликозилаза (UDG) |
||||||||||||
|
1922
|
|
1000 единиц
|
транспортировка -20°C
|
|
По запросу По запросу |
|
|
|
||||
|
Урацил-ДНК-гликозилаза (UDG) эффективно гидролизует урацил из одно- и двуцепочечных ДНК, но не из олигомеров, оптимальная температура – 37 °С,
хранение при -20 °С, срок хранения 2 года. Рекомбинантная форма, выделенная из E. coli. Буфер хранения: 20 мМ трис-HCl рН 8,2, 50 мМ NaCl, 1 мМ ЭДТА, 1 мМ ДТТ; 0,1 мг/мл БСА, 50% глицерина. Хранить при -20 °С. Условия реакции: 20 мМ трис-HCl рН 8,2, 1 мМ ЭДТА, 10 мМ NaCl. Определение единицы активности: за 1 единицу приняли количество фермента, необходимое для высвобождения 60 пмолей урацила за 1 минуту из двуцепочечной урацил-содержащей ДНК при 37 °С. Хранение и транспортировка при -20 °С. |
||||||||||||
|
1918
|
|
1000 единиц
|
транспортировка -20°C
|
|
1 040, руб.
1 040, руб. RUB
|
|
|
|
||||
|
Рекомбинантная форма, выделенная из E. coli, не содержит доменa РНКазы Н Буфер хранения:
50 мМ трис-HCl, pH 8,0 (при 25°C ), 100 мМ NaCl, 1 мМ ЭДТА, 5 мМ дитиотрейтол, 50 % глицерин и 0,1 % NP-40. Условия определения активности:
50 мМ трис-HCl, pH 8,3 (при 25°С), 40 мМ KCl, 6 мМ KCl, 50 мM [3H] dTTP, 1 мМ дитиотрейтол, poly А 2 А260/мл, 2 мкМ d(pT)12, 100 мкг/мл БСА. Определение активности:
За единицу активности принимали количество фермента, катализирующее включение 1 нмоль dTMP в кислотонерастворимый продукт за 10 мин при 37°С. Хранение и транспортировка: -20°С
|
||||||||||||
|
1968.1000
|
|
10000 единиц
|
хранение -20°C
|
|
9 277, руб.
9 277, руб. RUB
|
|
|
|
||||
|
Область применения: синтез первой цепи кДНК для ОТ-ПЦР и ОТ-ПЦР в режиме реального времени, синтез кДНК для клонирования, получение меченых кДНК-зондов для микрочипов (microarray), мечение ДНК, анализ РНК с помощью праймер-экстеншн.
|
||||||||||||
|
|
||||||||||||

|
Широкий выбор стандартных дезоксинуклеозидтрифосфатов (dNTP) и нуклеозидтрифосфатов (NTP), а также их модифицированных форм; в водном растворе или в ТЕ-буфере в виде солей K⁺, Li⁺, Na⁺, NH₄⁺ (по выбору); как по отдельности, так и в наборах по четыре. Каждый трифосфат поставляется в отдельной пробирке, свободен от примесей эндо-, экзонуклеаз, рибонуклеаз, фосфатаз, следовых количеств ДНК и нуклеотидов, протестирован in vitro; допускается многократное размораживание/замораживание. Нуклеозидтрифосфаты и дезоксинуклеозидтрифосфаты синтезированы химическим путем и очищены ионнообменной хроматографией; стандартные нуклеозидтрифосфаты используются как компоненты буферных растворов и реакционных смесей, в качестве субстрата в реакции матричного синтеза ДНК (ПЦР или секвенирование) и РНК. Модифицированные нуклеозидтрифосфаты используются в качестве терминирующих аналогов трифосфатов при секвенировании, для ферментативного непрямого нерадиоактивного мечения РНК/ДНК, например, введения флуоресцентной метки в ДНК, для исследования взаимодействий полимераза-субстрат и других молекулярно-биологических задач. |

|

|

|
|
1990
|
|
4х100 мкл
|
транспортировка -20°C
|
|
2 405, руб.
2 405, руб. RUB
|
|
|
|
||||
Условия хранения: -20 °С, допускается многократное размораживание или замораживание. |
||||||||||||
|
1991
|
|
4х100 мкл
|
транспортировка -20°C
|
|
2 405, руб.
2 405, руб. RUB
|
|
|
|
||||
Условия хранения: -20 °С, допускается многократное размораживание или замораживание. |
||||||||||||
|
1992.0100
|
|
100 мкл
|
хранение -20°C, транспортировка -20°C
|
|
610, руб.
610, руб. RUB
|
|
|
|
||||
|
100 мМ раствор аммонийной соли в стерильной воде, либо в ТЕ-буфере. Чистота препарата — не менее 99 % (по ВЭЖХ). |
||||||||||||
|
2010.0100
|
|
100 мкл
|
|
610, руб.
610, руб. RUB
|
|
|
|
|||||
|
100 мМ раствор аммонийной соли в стерильной воде, либо в ТЕ-буфере. Чистота препарата — не менее 99 % (по ВЭЖХ). |
||||||||||||
|
2017.0100
|
|
100 мкл
|
|
700, руб.
700, руб. RUB
|
|
|
|
|||||
|
100 мМ раствор аммонийной соли в стерильной воде, либо в ТЕ-буфере.
Чистота препарата — не менее 99 % (по ВЭЖХ). |
||||||||||||
|
2021.0100
|
|
100 мкл
|
|
610, руб.
610, руб. RUB
|
|
|
|
|||||
|
100 мМ раствор аммонийной соли в стерильной воде, либо в ТЕ-буфере.
Чистота препарата — не менее 99 % (по ВЭЖХ). |
||||||||||||
|
2018.0100
|
|
100 мкл
|
|
474, руб.
474, руб. RUB
|
|
|
|
|||||
|
100 мМ раствор аммонийной соли в стерильной воде, либо в ТЕ-буфере.
Чистота препарата — не менее 99 % (по ВЭЖХ). |
||||||||||||
|
1914
|
|
4х100 мкл
|
транспортировка -20°C
|
|
2 754, руб.
2 754, руб. RUB
|
|
|
|
||||
|
Поставляются в виде 100 мМ раствора в воде как наборами по 4 нуклеотида, так и по отдельности, нуклеотиды очищены ионнообменной колоночной хроматографией.
Условия хранения: -20 °С, допускается транспортировка в температуре окружающей среды. |
||||||||||||
|
2001.0100
|
|
100 мкл
|
хранение -20°C
|
|
697, руб.
697, руб. RUB
|
|
|
|
||||
|
100 мМ раствор аммонийной соли в стерильной воде, либо в ТЕ-буфере.
Чистота препарата — не менее 99 % (по ВЭЖХ). |
||||||||||||
|
2002.0100
|
|
100 мкл
|
|
По запросу По запросу |
|
|
|
|||||
|
100 мМ раствор аммонийной соли в стерильной воде, либо в ТЕ-буфере.
Чистота препарата — не менее 99 % (по ВЭЖХ). |
||||||||||||
|
2003.0100
|
|
100 мкл
|
хранение -20°C
|
|
602, руб.
602, руб. RUB
|
|
|
|
||||
|
100 мМ раствор аммонийной соли в стерильной воде, либо в ТЕ-буфере.
Чистота препарата — не менее 99 % (по ВЭЖХ). |
||||||||||||
|
2004.0100
|
|
100 мкл
|
|
По запросу По запросу |
|
|
|
|||||
|
100 мМ раствор аммонийной соли в стерильной воде, либо в ТЕ-буфере.
Чистота препарата — не менее 99 % (по ВЭЖХ). |
||||||||||||
|
|
||||||||||||
|
2006.0100
|
|
100 мкл
|
|
9 965, руб.
9 965, руб. RUB
|
|
|
|
|||||
|
Терминирующий аналог dATP для секвенирования. Условия хранения: -20 °С, допускается на короткий период (до 1 недели) хранение при комнатной температуре. |
||||||||||||
|
2007.0100
|
|
100 мкл
|
|
9 965, руб.
9 965, руб. RUB
|
|
|
|
|||||
|
Терминирующий аналог dGTP для секвенирования.
Условия хранения: -20 °С, допускается на короткий период (до 1 недели) хранение при комнатной температуре. |
||||||||||||
|
2008.0100
|
|
100 мкл
|
|
9 965, руб.
9 965, руб. RUB
|
|
|
|
|||||
|
Терминирующий аналог dUTP для секвенирования. Условия хранения: -20 °С, допускается на короткий период (до 1 недели) хранение при комнатной температуре. |
||||||||||||
|
2009.0100
|
|
100 мкл
|
|
По запросу По запросу |
|
|
|
|||||
|
Терминирующий аналог dCTP для секвенирования. Условия хранения: -20 °С, допускается на короткий период (до 1 недели) хранение при комнатной температуре. |
||||||||||||
|
diaGene, Россия
ddTTP (2’,3’-Дидезокситимидин-5’-трифосфат), 10 мМ, NH₄⁺ |
||||||||||||
|
3441.0100
|
|
100 мкл
|
|
9 965, руб.
9 965, руб. RUB
|
|
|
|
|||||
|
2011.0001
|
|
1 мг
|
|
5 633, руб.
5 633, руб. RUB
|
|
|
|
|||||
|
2012.0001
|
|
1 мг
|
|
5 633, руб.
5 633, руб. RUB
|
|
|
|
|||||
|
Терминирующий трифосфат, аналог трифосфатов на основе 2',3'-дидезоксинуклеозидов. Условия хранения: -20 °С. |
||||||||||||
|
2013.0001
|
|
1 мг
|
|
5 633, руб.
5 633, руб. RUB
|
|
|
|
|||||
|
Терминирующий трифосфат, аналог трифосфатов на основе 2',3'-дидезоксинуклеозидов. Условия хранения: -20 °С. |
||||||||||||
|
2014.0001
|
|
1 мг
|
|
5 633, руб.
5 633, руб. RUB
|
|
|
|
|||||
|
Терминирующий трифосфат, аналог трифосфатов на основе 2',3'-дидезоксинуклеозидов. Условия хранения: -20 °С. |
||||||||||||
|
|
||||||||||||
|
1996.0100
|
|
100 мкл
|
|
18 065, руб.
18 065, руб. RUB
|
|
|
|
|||||
|
N-305-100
|
|
100 мкл
|
хранение -20°C
|
|
29 507, руб.
29 507, руб. RUB
|
|
|
|
||||
|
5-[N-(N-биотинил- e- аминокапроил) -3- аминоаллил] -2’-дезоксиуридин -5’-трифосфат (Био-11-dUTP) широко используется для нерадиоактивного мечения ДНК.
Био-11-dUTP ферментативно вводится в ДНК посредством ник-трансляции, методом random priming, мечением 3’-конца или с помощью ПЦР. Число "11" означает количество атомов углерода в цепочке между dUTP и биотином. Длина "11" оптимальна для большинства приложений. Условия хранения: -20 °С, допускается многократное размораживание или замораживание. |
||||||||||||
|
1998.0100
|
|
100 мкл
|
хранение -20°C, транспортировка сухой лед
|
|
20 740, руб.
20 740, руб. RUB
|
|
|
|
||||
|
5-{(7-N-(6-N-(биотинил)аминокапроил) -амино-4-окса-гепт-1-инил)-2’-дезоксицитидин-5’-трифосфат (Био-15-dCTP) широко используется для нерадиоактивного мечения ДНК.
Био-11-dCTP ферментативно вводится в ДНК посредством ник-трансляции, методом random priming, мечением 3’-конца или с помощью ПЦР. Число "15" означает количество атомов углерода в цепочке между dCTP и биотином. Длина "15" оптимальна для большинства приложений. Условия хранения: -20 °С, допускается многократное размораживание или замораживание. |
||||||||||||
|
1999.0100
|
|
100 мкл
|
транспортировка -20°C
|
|
По запросу По запросу |
|
|
|
||||
|
Реагент для непрямого ферментативного нерадиоактивного мечения ДНК. BrdUTP используется для включения в ДНК для последующей детекции с помощью анти-BrdU антител.
Включение BrdUTP в ДНК также является средством внечения случайных мутаций. Условия хранения: -20 °С, допускается многократное размораживание или замораживание. |
||||||||||||
|
2015
|
|
|
|
По запросу По запросу |
|
|
|
|||||
|
Для анализа степени оксидативного повреждения ДНК и изучения последующей репарации ДНК.
|
||||||||||||
|
2016.010
|
|
100 мкл
|
|
По запросу По запросу |
|
|
|
|||||
|
Реагент для введения флуоресцентной метки в ДНК. Условия хранения: -20 °С. |
||||||||||||
|
2020.0100
|
|
100 мкл
|
|
10 140, руб.
10 140, руб. RUB
|
|
|
|
|||||
|
Реагент для мечения ДНК с использованием ПЦР. Условия хранения: -20 °С. |
||||||||||||
|
|
||||||||||||

|
1906.0250
|
|
250 мкг
|
транспортировка -20°C
|
|
9 342, руб.
9 342, руб. RUB
|
|
|
|
||||
Особенности ДНК-маркера 1000/10C
|
||||||||||||
|
1930.0250
|
|
250 мкг
|
транспортировка -20°C
|
|
9 342, руб.
9 342, руб. RUB
|
|
|
|
||||
Особенности ДНК-маркера 1000/10C
|
||||||||||||
|
1911.0250
|
|
250 мкг
|
транспортировка -20°C
|
|
9 342, руб.
9 342, руб. RUB
|
|
|
|
||||
Особенности ДНК-маркера 1000/10R
|
||||||||||||
|
1907.0250
|
|
250 мкг
|
хранение -20°C
|
|
8 201, руб.
8 201, руб. RUB
|
|
|
|
||||
|
Маркер ДНК (DNA marker) — это фрагменты ДНК, которые используются в генетике для оценки размеров фрагментов ДНК в ходе электрофореза. Маркеры ДНК представляют собой специально подобранные фрагменты ДНК различных известных длин, которые добавляются к образцам ДНК перед проведением электрофореза. После окончания электрофореза маркеры ДНК помогают оценить размеры фрагментов ДНК в образцах путем сравнения расстояний, которые пройдены фрагментами маркера и образцами в геле. Харктеристики ДНК-маркера 3000/8С
|
||||||||||||
|
1910
|
|
50 мкг
|
транспортировка -20°C
|
|
2 659, руб.
2 659, руб. RUB
|
|
|
|
||||
|
Маркер молекулярного веса ДНК содержит 8 фрагментов от 250 до 3000 п.н.; фрагменты 250, 500, 750, 1000, 1500, 2000, 2500 и 3000 п.н.; концентрация ДНК-маркера — 0,1 мг/мл; предварительно смешан с буфером для нанесения; рекомендуемый объём для нанесения на гель — 2 мкл; условия хранения: -20 °C.
|
||||||||||||
|
1905.0250
|
|
250 мкг
|
транспортировка -20°C
|
|
9 342, руб.
9 342, руб. RUB
|
|
|
|
||||
Особенности ДНК-маркера 10000/13C
|
||||||||||||
|
3012
|
|
1 мл
|
хранение -20°C, транспортировка комнатная температура
|
|
583, руб.
583, руб. RUB
|
|
|
|
||||
|
Буфер для хранения и нанесения образцов, содержит 2 красителя для оценки подвижности в геле,
состав: 12,5 % глицерин, 0,008% бромфеноловый синий, 0,008% ксиленцианол, 5 мМ ЭДТА, 10 мМTris-HCl (pH 8,0). |
||||||||||||
|
3013
|
|
1 мл
|
хранение -20°C
|
|
583, руб.
583, руб. RUB
|
|
|
|
||||
|
Буфер для хранения и нанесения образцов, содержит 3 красителя для оценки подвижности в геле,
состав: 60 % глицерин, 0,003% бромфеноловый синий, 0,003% ксиленцианол, 0,15% оранжевый G, 60 мМ ЭДТА, 10 мМTris-HCl (pH 7,6). |
||||||||||||
|
|
||||||||||||


|
|

|

|
|
3183
|
|
|
|
По запросу По запросу |
|
|
|
|||||||||||||||||||||||||||||||||||||||||||||||||||||||||||||||||||||||||||||||||||||||||||||||||||||||||||
|
Товар временно недоступен. Аналоги по запросу ниже. Предназначены для работы с 96-ти луночными планшетами, при этом могут быть использованы совместно как со стандартными низкопрофильными, так и высокопрофильными планшетами (2000 мкл); стерилизация в пламени горелки или в автоклаве.
|
||||||||||||||||||||||||||||||||||||||||||||||||||||||||||||||||||||||||||||||||||||||||||||||||||||||||||||||||||
|
3184
|
|
|
|
По запросу По запросу |
|
|
|
|||||||||||||||||||||||||||||||||||||||||||||||||||||||||||||||||||||||||||||||||||||||||||||||||||||||||||
|
Товар временно недоступен. Аналоги по запросу ниже.
Репликатор совместим с круглыми чашками Петри диаметром 40 мм.
|
||||||||||||||||||||||||||||||||||||||||||||||||||||||||||||||||||||||||||||||||||||||||||||||||||||||||||||||||||
|
3185
|
|
|
|
По запросу По запросу |
|
|
|
|||||||||||||||||||||||||||||||||||||||||||||||||||||||||||||||||||||||||||||||||||||||||||||||||||||||||||
|
Товар временно недоступен. Аналоги по запросу ниже.
Репликатор совместим с круглыми чашками Петри диаметром 40 мм.
|
||||||||||||||||||||||||||||||||||||||||||||||||||||||||||||||||||||||||||||||||||||||||||||||||||||||||||||||||||
|
3186
|
|
|
|
По запросу По запросу |
|
|
|
|||||||||||||||||||||||||||||||||||||||||||||||||||||||||||||||||||||||||||||||||||||||||||||||||||||||||||
|
Товар временно недоступен. Аналоги по запросу ниже.
Репликатор совместим с круглыми чашками Петри диаметром 40 мм.
|
||||||||||||||||||||||||||||||||||||||||||||||||||||||||||||||||||||||||||||||||||||||||||||||||||||||||||||||||||
|
3187
|
|
|
|
По запросу По запросу |
|
|
|
|||||||||||||||||||||||||||||||||||||||||||||||||||||||||||||||||||||||||||||||||||||||||||||||||||||||||||
|
Товар временно недоступен. Аналоги по запросу ниже. Матричная плашка имеет 28 лунок с d 4 мм и глубиной 11 мм, стерилизуется автоклавированием. |
||||||||||||||||||||||||||||||||||||||||||||||||||||||||||||||||||||||||||||||||||||||||||||||||||||||||||||||||||
|
3188
|
|
|
|
По запросу По запросу |
|
|
|
|||||||||||||||||||||||||||||||||||||||||||||||||||||||||||||||||||||||||||||||||||||||||||||||||||||||||||
|
Товар временно недоступен. Аналоги по запросу ниже.
Репликатор совместим с круглыми чашками Петри диаметром 86 мм.
|
||||||||||||||||||||||||||||||||||||||||||||||||||||||||||||||||||||||||||||||||||||||||||||||||||||||||||||||||||
|
3189
|
|
|
|
По запросу По запросу |
|
|
|
|||||||||||||||||||||||||||||||||||||||||||||||||||||||||||||||||||||||||||||||||||||||||||||||||||||||||||
|
Товар временно недоступен. Аналоги по запросу ниже. |
||||||||||||||||||||||||||||||||||||||||||||||||||||||||||||||||||||||||||||||||||||||||||||||||||||||||||||||||||
|
3190
|
|
|
|
По запросу По запросу |
|
|
|
|||||||||||||||||||||||||||||||||||||||||||||||||||||||||||||||||||||||||||||||||||||||||||||||||||||||||||
|
Товар временно недоступен. Аналоги по запросу ниже.
Репликатор совместим с круглыми чашками Петри диаметром 86 мм.
|
||||||||||||||||||||||||||||||||||||||||||||||||||||||||||||||||||||||||||||||||||||||||||||||||||||||||||||||||||
|
3191
|
|
|
|
33 690, руб.
33 690, руб. RUB
|
|
|
|
|||||||||||||||||||||||||||||||||||||||||||||||||||||||||||||||||||||||||||||||||||||||||||||||||||||||||||
|
Товар временно недоступен. Аналоги по запросу ниже.
Репликатор совместим с круглыми чашками Петри диаметром 86 мм.
|
||||||||||||||||||||||||||||||||||||||||||||||||||||||||||||||||||||||||||||||||||||||||||||||||||||||||||||||||||
|
3192
|
|
|
|
По запросу По запросу |
|
|
|
|||||||||||||||||||||||||||||||||||||||||||||||||||||||||||||||||||||||||||||||||||||||||||||||||||||||||||
|
Репликатор совместим с круглыми чашками Петри диаметром 86 мм.
|
||||||||||||||||||||||||||||||||||||||||||||||||||||||||||||||||||||||||||||||||||||||||||||||||||||||||||||||||||
|
103193
|
|
|
|
По запросу По запросу |
|
|
|
|||||||||||||||||||||||||||||||||||||||||||||||||||||||||||||||||||||||||||||||||||||||||||||||||||||||||||
|
||||||||||||||||||||||||||||||||||||||||||||||||||||||||||||||||||||||||||||||||||||||||||||||||||||||||||||||||||
|
3194
|
|
|
|
По запросу По запросу |
|
|
|
|||||||||||||||||||||||||||||||||||||||||||||||||||||||||||||||||||||||||||||||||||||||||||||||||||||||||||
|
Товар временно недоступен. Аналоги по запросу ниже.
Репликатор совместим с квадратными чашками Петри размером 120x120 мм.
|
||||||||||||||||||||||||||||||||||||||||||||||||||||||||||||||||||||||||||||||||||||||||||||||||||||||||||||||||||
|
3195
|
|
|
|
43 575, руб.
43 575, руб. RUB
|
|
|
|
|||||||||||||||||||||||||||||||||||||||||||||||||||||||||||||||||||||||||||||||||||||||||||||||||||||||||||
|
Товар временно недоступен. Аналоги по запросу ниже.
Репликатор совместим с квадратными чашками Петри размером 120x120 мм.
|
||||||||||||||||||||||||||||||||||||||||||||||||||||||||||||||||||||||||||||||||||||||||||||||||||||||||||||||||||
|
3196
|
|
|
|
По запросу По запросу |
|
|
|
|||||||||||||||||||||||||||||||||||||||||||||||||||||||||||||||||||||||||||||||||||||||||||||||||||||||||||
|
Товар временно недоступен. Аналоги по запросу ниже.
Репликатор совместим с квадратными чашками Петри размером 120x120 мм.
|
||||||||||||||||||||||||||||||||||||||||||||||||||||||||||||||||||||||||||||||||||||||||||||||||||||||||||||||||||
|
3197
|
|
|
|
По запросу По запросу |
|
|
|
|||||||||||||||||||||||||||||||||||||||||||||||||||||||||||||||||||||||||||||||||||||||||||||||||||||||||||
|
Товар временно недоступен. Аналоги по запросу ниже.
Репликатор совместим с квадратными чашками Петри размером 120x120 мм.
|
||||||||||||||||||||||||||||||||||||||||||||||||||||||||||||||||||||||||||||||||||||||||||||||||||||||||||||||||||
|
3198
|
|
|
|
По запросу По запросу |
|
|
|
|||||||||||||||||||||||||||||||||||||||||||||||||||||||||||||||||||||||||||||||||||||||||||||||||||||||||||
|
Товар временно недоступен. Аналоги по запросу ниже.
Репликатор совместим с квадратными чашками Петри размером 120x120 мм.
|
||||||||||||||||||||||||||||||||||||||||||||||||||||||||||||||||||||||||||||||||||||||||||||||||||||||||||||||||||
|
3199
|
|
|
|
По запросу По запросу |
|
|
|
|||||||||||||||||||||||||||||||||||||||||||||||||||||||||||||||||||||||||||||||||||||||||||||||||||||||||||
|
Товар временно недоступен. Аналоги по запросу ниже. Матричная плашка имеет 144 лунки с d 6 мм и глубиной 11 мм, стерилизуется автоклавированием. С данной матричной плашкой может быть использован репликатор с подвижными пинами для 96-ти луночных планшет, обеспечивающий полный перенос из планшета за два подхода. |
||||||||||||||||||||||||||||||||||||||||||||||||||||||||||||||||||||||||||||||||||||||||||||||||||||||||||||||||||
|
3200
|
|
|
|
По запросу По запросу |
|
|
|
|||||||||||||||||||||||||||||||||||||||||||||||||||||||||||||||||||||||||||||||||||||||||||||||||||||||||||
|
Товар временно недоступен. Аналоги по запросу ниже.
Репликатор совместим с культуральными планшетами с 48 лунками (6x8 лунок) производства Eppendorf.
|
||||||||||||||||||||||||||||||||||||||||||||||||||||||||||||||||||||||||||||||||||||||||||||||||||||||||||||||||||
|
3201
|
|
|
|
По запросу По запросу |
|
|
|
|||||||||||||||||||||||||||||||||||||||||||||||||||||||||||||||||||||||||||||||||||||||||||||||||||||||||||
|
Товар временно недоступен. Аналоги по запросу ниже.
Репликатор совместим с культуральными планшетами с 48 лунками (6x8 лунок) производства Eppendorf.
|
||||||||||||||||||||||||||||||||||||||||||||||||||||||||||||||||||||||||||||||||||||||||||||||||||||||||||||||||||
|
3202
|
|
|
|
По запросу По запросу |
|
|
|
|||||||||||||||||||||||||||||||||||||||||||||||||||||||||||||||||||||||||||||||||||||||||||||||||||||||||||
|
Товар временно недоступен. Аналоги по запросу ниже.
Репликатор совместим с культуральными планшетами с 48 лунками (6x8 лунок) производства Eppendorf.
|
||||||||||||||||||||||||||||||||||||||||||||||||||||||||||||||||||||||||||||||||||||||||||||||||||||||||||||||||||
|
3203
|
|
|
|
По запросу По запросу |
|
|
|
|||||||||||||||||||||||||||||||||||||||||||||||||||||||||||||||||||||||||||||||||||||||||||||||||||||||||||
|
Товар временно недоступен. Аналоги по запросу ниже.
Репликатор совместим с культуральными планшетами с 48 лунками (6x8 лунок) производства Eppendorf.
|
||||||||||||||||||||||||||||||||||||||||||||||||||||||||||||||||||||||||||||||||||||||||||||||||||||||||||||||||||
|
3204
|
|
|
|
По запросу По запросу |
|
|
|
|||||||||||||||||||||||||||||||||||||||||||||||||||||||||||||||||||||||||||||||||||||||||||||||||||||||||||
|
Товар временно недоступен. Аналоги по запросу ниже.
Репликатор совместим с культуральными планшетами с 48 лунками (6x8 лунок) производства Eppendorf.
|
||||||||||||||||||||||||||||||||||||||||||||||||||||||||||||||||||||||||||||||||||||||||||||||||||||||||||||||||||
|
3205
|
|
|
|
28 250, руб.
28 250, руб. RUB
|
|
|
|
|||||||||||||||||||||||||||||||||||||||||||||||||||||||||||||||||||||||||||||||||||||||||||||||||||||||||||
|
Товар временно недоступен. Аналоги по запросу ниже.
Репликатор совместим с культуральными планшетами на 96 лунок.
|
||||||||||||||||||||||||||||||||||||||||||||||||||||||||||||||||||||||||||||||||||||||||||||||||||||||||||||||||||
|
3206
|
|
|
|
По запросу По запросу |
|
|
|
|||||||||||||||||||||||||||||||||||||||||||||||||||||||||||||||||||||||||||||||||||||||||||||||||||||||||||
|
Товар временно недоступен. Аналоги по запросу ниже.
Репликатор совместим с культуральными планшетами на 96 лунок.
|
||||||||||||||||||||||||||||||||||||||||||||||||||||||||||||||||||||||||||||||||||||||||||||||||||||||||||||||||||
|
3207
|
|
|
|
По запросу По запросу |
|
|
|
|||||||||||||||||||||||||||||||||||||||||||||||||||||||||||||||||||||||||||||||||||||||||||||||||||||||||||
|
Товар временно недоступен. Аналоги по запросу ниже.
Репликатор совместим с культуральными планшетами на 96 лунок.
|
||||||||||||||||||||||||||||||||||||||||||||||||||||||||||||||||||||||||||||||||||||||||||||||||||||||||||||||||||
|
3208
|
|
|
|
По запросу По запросу |
|
|
|
|||||||||||||||||||||||||||||||||||||||||||||||||||||||||||||||||||||||||||||||||||||||||||||||||||||||||||
|
Товар временно недоступен. Аналоги по запросу ниже.
Репликатор совместим с культуральными планшетами на 96 лунок.
|
||||||||||||||||||||||||||||||||||||||||||||||||||||||||||||||||||||||||||||||||||||||||||||||||||||||||||||||||||
|
3209
|
|
|
|
По запросу По запросу |
|
|
|
|||||||||||||||||||||||||||||||||||||||||||||||||||||||||||||||||||||||||||||||||||||||||||||||||||||||||||
|
Товар временно недоступен. Аналоги по запросу ниже.
Репликатор совместим с культуральными планшетами на 96 лунок.
|
||||||||||||||||||||||||||||||||||||||||||||||||||||||||||||||||||||||||||||||||||||||||||||||||||||||||||||||||||
|
3210
|
|
|
|
По запросу По запросу |
|
|
|
|||||||||||||||||||||||||||||||||||||||||||||||||||||||||||||||||||||||||||||||||||||||||||||||||||||||||||
|
Товар временно недоступен. Аналоги по запросу ниже.
Репликатор предназначен для работы с 96-луночными планшетами, может быть использован совместно со стандартными низкопрофильными и высокопрофильными (2000 мкл) планшетами.
|
||||||||||||||||||||||||||||||||||||||||||||||||||||||||||||||||||||||||||||||||||||||||||||||||||||||||||||||||||
|
3211
|
|
|
|
По запросу По запросу |
|
|
|
|||||||||||||||||||||||||||||||||||||||||||||||||||||||||||||||||||||||||||||||||||||||||||||||||||||||||||
|
Товар временно недоступен. Аналоги по запросу ниже.
Репликатор предназначен для работы с 96-луночными планшетами, может быть использован совместно со стандартными низкопрофильными и высокопрофильными (2000 мкл) планшетами.
|
||||||||||||||||||||||||||||||||||||||||||||||||||||||||||||||||||||||||||||||||||||||||||||||||||||||||||||||||||
|
3212
|
|
|
|
По запросу По запросу |
|
|
|
|||||||||||||||||||||||||||||||||||||||||||||||||||||||||||||||||||||||||||||||||||||||||||||||||||||||||||
|
Товар временно недоступен. Аналоги по запросу ниже.
Репликатор предназначен для работы с 96-луночными планшетами, может быть использован совместно со стандартными низкопрофильными и высокопрофильными (2000 мкл) планшетами.
|
||||||||||||||||||||||||||||||||||||||||||||||||||||||||||||||||||||||||||||||||||||||||||||||||||||||||||||||||||
|
3213
|
|
|
|
29 145, руб.
29 145, руб. RUB
|
|
|
|
|||||||||||||||||||||||||||||||||||||||||||||||||||||||||||||||||||||||||||||||||||||||||||||||||||||||||||
|
Товар временно недоступен. Аналоги по запросу ниже.
Репликатор предназначен для работы с 96-луночными планшетами, может быть использован совместно со стандартными низкопрофильными и высокопрофильными (2000 мкл) планшетами.
|
||||||||||||||||||||||||||||||||||||||||||||||||||||||||||||||||||||||||||||||||||||||||||||||||||||||||||||||||||
|
3214
|
|
|
|
По запросу По запросу |
|
|
|
|||||||||||||||||||||||||||||||||||||||||||||||||||||||||||||||||||||||||||||||||||||||||||||||||||||||||||
|
Товар временно недоступен. Аналоги по запросу ниже.
Репликатор предназначен для работы с 96-луночными планшетами, может быть использован совместно со стандартными низкопрофильными и высокопрофильными (2000 мкл) планшетами.
|
||||||||||||||||||||||||||||||||||||||||||||||||||||||||||||||||||||||||||||||||||||||||||||||||||||||||||||||||||
|
3215
|
|
|
|
По запросу По запросу |
|
|
|
|||||||||||||||||||||||||||||||||||||||||||||||||||||||||||||||||||||||||||||||||||||||||||||||||||||||||||
|
Товар временно недоступен. Аналоги по запросу ниже.
Репликатор предназначен для работы с 384-луночными планшетами.
|
||||||||||||||||||||||||||||||||||||||||||||||||||||||||||||||||||||||||||||||||||||||||||||||||||||||||||||||||||
|
|
||||||||||||||||||||||||||||||||||||||||||||||||||||||||||||||||||||||||||||||||||||||||||||||||||||||||||||||||||

|
3334
|
|
|
|
3 600, руб.
3 600, руб. RUB
|
|
|
|
|||||
|
Магнитные сепараторы применяются для выделения и очистки биомолекул и клеток с использованием технологии магнитных частиц. Иммобилизованные субстраты остаются биологически активными, возможно дальнейшее их элюирование.
|
||||||||||||
|
3335
|
|
|
|
По запросу По запросу |
|
|
|
|||||
|
Магнитные сепараторы применяются для выделения и очистки биомолекул и клеток с использованием технологии магнитных частиц. Иммобилизованные субстраты остаются биологически активными, возможно дальнейшее их элюирование.
|
||||||||||||
|
3336
|
|
|
|
10 500, руб.
10 500, руб. RUB
|
|
|
|
|||||
|
Магнитные сепараторы применяются для выделения и очистки биомолекул и клеток с использованием технологии магнитных частиц. Иммобилизованные субстраты остаются биологически активными, возможно дальнейшее их элюирование.
|
||||||||||||
|
3337
|
|
|
|
17 500, руб.
17 500, руб. RUB
|
|
|
|
|||||
|
Магнитные сепараторы применяются для выделения и очистки биомолекул и клеток с использованием технологии магнитных частиц. Иммобилизованные субстраты остаются биологически активными, возможно дальнейшее их элюирование.
|
||||||||||||
|
3413
|
|
|
|
По запросу По запросу |
|
|
|
|||||
|
||||||||||||
|
12321D
|
|
|
|
179 000, руб.
179 000, руб. RUB
|
|
|
|
|||||
|
Магнитный штатив DynaMag-2 оптимизирован для эффективного магнитного разделения с магнитными частицами Dynabeads (диапазон диаметров 1-4,5 мкм) в небольших объемах образцов.
|
||||||||||||
|
12027
|
|
|
|
255 000, руб.
255 000, руб. RUB
|
|
|
|
|||||
|
Штативы DynaMag предназначены для сепарации с использованием магнитных частиц Dynabeads; позволяют проводить сепарацию в объеме 5–200 мкл, используя ПЦР-стрипы или 96-луночные ПЦР-планшеты; магнитные частицы концентрируются на дне (DynaMag-96 Bottom) или на стенке пробирок (DynaMag-96 Side и DynaMag-96 Side Skirted). |
||||||||||||
|
12332D
|
|
|
|
По запросу По запросу |
|
|
|
|||||
|
Штативы DynaMag предназначены для сепарации с использованием магнитных частиц Dynabeads; позволяют проводить сепарацию в объеме 5–200 мкл, используя ПЦР-стрипы или 96-луночные ПЦР-планшеты; магнитные частицы концентрируются на дне (DynaMag-96 Bottom) или на стенке пробирок (DynaMag-96 Side и DynaMag-96 Side Skirted). |
||||||||||||
|
Beckman Coulter
Магнитный штатив Agencourt SPRIStand - Magnetic 6-tube Stand |
||||||||||||
|
A29182
|
|
|
|
По запросу По запросу |
|
|
|
|||||
|
A63880
|
|
5 мл
|
хранение +2...+8°C, транспортировка +2...+8 °C
|
|
96 369, руб.
|
|
|
|
||||
|
Магнитные частицы Agencourt AMPure XP для очистки ДНК от продуктов ПЦР и на стадиях подготовки библиотек для секвенирования, производит ДНК высшего качества без переноса соли, не требует центрифугирования или фильтрации.
|
||||||||||||
|
Thermo FS
Магнитные частицы Dynabeads CD45 |
||||||||||||
|
11153D
|
|
|
хранение +2...+8°C, транспортировка комнатная температура
|
|
331 000, руб.
331 000, руб. RUB
|
|
|
|
||||
|
|
||||||||||||

|

|

|

|

|

|
|
Гель D5 LE в 1хТАЕ буфере: D – 0,5%, E – 1%, F – 1,5%. 1 – ДНК фага λ + Hindlll; 2 – pBR328 + Bgll и pBR328 + Hinfl. |
Гель MS-8 3% в 1хТAЕ буфере: 1 – маркер 250 bp, 2 – маркер 100 bp, 3 – маркер V, 4 – маркер 10 bp. |
Гель LM Sieve в 1хТBЕ буфере: A – 2%, B – 3%, C – 4%. 1 – pBR328 + Mspl, 2 – ФX174DNA + Haelll. |
|
diaGene, Россия
Агароза, низкий EEO, LM, легкоплавкая |
|||||||||||||||||||||||||||||||||||||||||||
|
1926.0025
|
|||||||||||||||||||||||||||||||||||||||||||
|
Для разделения фрагментов НК более 1000 п.н.; для аналитического и препаративного электрофореза НК. Низкая температура плавления позволяет проводить манипуляции с НК, не экстрагируя из геля.
Скачать: Агарозы LM и LM GQT, техническая инструкция, англ., 1 стр., 157 kB
См. таже: Какие факторы необходимо учитывать при выборе типа агарозы. Таблица выбора агарозы в зависимости от задачи исследования. Таблица выбора агарозы в зависимости от размеров целевых фрагментов.
|
|||||||||||||||||||||||||||||||||||||||||||
|
1924.0025
|
|||||||||||||||||||||||||||||||||||||||||||
|
Для разделения фрагментов НК и ПЦР продукта от 200 до 800 п.н.; для аналитического и препаративного электрофореза НК. Genetic Quality Tested – подходит для обработки агаразой, что позволяет легко восстанавливать небольшие фрагменты ДНК для клонирования и энзиматического расщепления; подходит для энзиматической обработки НК (лигирования, расщепления) в геле без предварительной экстракции.
Скачать:
См. также:
|
|||||||||||||||||||||||||||||||||||||||||||
|
diaGene, Россия
Агароза, низкий EEO, E, для рутинного электрофореза |
|||||||||||||||||||||||||||||||||||||||||||
|
1927.0025
|
|||||||||||||||||||||||||||||||||||||||||||
|
Для разделения фрагментов НК от 250 п.н. до 23 тыс.п.н.; для аналитического и препаративного электрофореза НК, разделения плазмид для клонирования, блоттинга, радиальной иммунодиффузии. Оптимальная концентрация геля 0,75-2,0 %. Скачать: Агароза E, техническая инструкция, англ., 1 стр., 442 kB См. также: Таблица выбора агарозы в зависимости от размеров целевых фрагментов.
|
|||||||||||||||||||||||||||||||||||||||||||
|
diaGene, Россия
Агароза, низкий EEO, D1, (аналог арт. 911120 .10 gm, CDH) |
|||||||||||||||||||||||||||||||||||||||||||
|
1929.0025
|
|||||||||||||||||||||||||||||||||||||||||||
|
Для разделения фрагментов НК более 1000 п.н.; для аналитического и препаративного электрофореза НК, блоттинга, радиальной иммунодиффузии Скачать: Агароза D1, техническая инструкция, англ., 1 стр., 95 kB
См. также:
|
|||||||||||||||||||||||||||||||||||||||||||
|
diaGene, Россия
Агароза, низкий EEO, D1, GQT, Genetic Quality Tested |
|||||||||||||||||||||||||||||||||||||||||||
|
1932.0025
|
|||||||||||||||||||||||||||||||||||||||||||
|
Для разделения фрагментов НК более 1000 п.н.; для аналитического и препаративного электрофореза НК, блоттинга. Genetic Quality Tested – тестирована на проведение препаративного электрофореза и восстановление ДНК без повреждения структуры и свойств.
См. также:
|
|||||||||||||||||||||||||||||||||||||||||||
|
diaGene, Россия
Агароза, средний EEO, D1, (аналог арт. 911050.10gm, CDH) |
|||||||||||||||||||||||||||||||||||||||||||
|
1948.0025
|
|||||||||||||||||||||||||||||||||||||||||||
|
Товар временно недоступен. Аналоги: арт. 911050.10gm, CDH.
Для разделения фрагментов НК более 1000 п.н.; для электрофореза НК и белкового электрофореза.
Скачать:
См. также:
|
|||||||||||||||||||||||||||||||||||||||||||
|
diaGene, Россия
Агароза, высокий EEO, D1, (аналог арт. 911010.10 gm, CDH) |
|||||||||||||||||||||||||||||||||||||||||||
|
1928.0025
|
|||||||||||||||||||||||||||||||||||||||||||
|
Для белкового электрофореза, иммуноэлектрофореза. Скачать: Агароза D1, техническая инструкция, англ., 1 стр., 95 kB См. таже: Таблица выбора агарозы в зависимости от размеров целевых фрагментов.
|
|||||||||||||||||||||||||||||||||||||||||||
|
1949.0025
|
|||||||||||||||||||||||||||||||||||||||||||
|
Товар временно недоступен. Аналоги: 911200.5g, 911200.25g, 911200.10g, 911200.100g, CDH, Индия.
Для разделения фрагментов НК более 1000 п.н.; для электрофореза НК и белкового электрофореза. Повышенная температура гелеобразования придает гелю большую устойчивость.
Скачать:
См. также:
|
|||||||||||||||||||||||||||||||||||||||||||
|
diaGene, Россия
Агароза, низкий EEO, D5, повышенная прочность геля |
|||||||||||||||||||||||||||||||||||||||||||
|
1950.0025
|
|||||||||||||||||||||||||||||||||||||||||||
|
Для разделения фрагментов НК более 1000 п.н.; для электрофореза НК , блоттинга, пульс-гель электрофореза. Повышенная прочность геля позволяет готовить гель низкой концентрации (0,3%) для разделения высокомолекулярных НК, а также больших частиц, как вирусы и рибосомы. Высокая электрофоретическая подвижность; широкий диапазон концентраций геля.
Скачать: См. также: Таблица выбора агарозы в зависимости от размеров целевых фрагментов.
|
|||||||||||||||||||||||||||||||||||||||||||
|
1931.0025
|
|
25 г
|
|
10 496, руб.
|
|
|
|
||||||||||||||||||||||||||||||||||||
|
Для разделения фрагментов НК менее 1200 п.н., для электрофореза НК и ПЦР-продукта, блоттинга. По четкости разделения фрагментов аналогичен ПААГ; гель с повышенной прозрачностью, ломкость минимизирована.
См. также:
|
|||||||||||||||||||||||||||||||||||||||||||
|
1945.0025
|
|||||||||||||||||||||||||||||||||||||||||||
|
Для разделения фрагментов НК более 1000 п.н.; для электрофореза НК , блоттинга, ДНК-фингерпринтирования. Не размывается, фрагменты при разделении четкие; нет различия по качеству между партиями.
Скачать: Агарозы D2 и FP DNA, техническая инструкция, англ., 1 стр., 69 kB
См. таже: Какие факторы необходимо учитывать при выборе типа агарозы. Таблица выбора агарозы в зависимости от задачи исследования. Таблица выбора агарозы в зависимости от размеров целевых фрагментов.
|
|||||||||||||||||||||||||||||||||||||||||||
|
1953.0025ф
|
|||||||||||||||||||||||||||||||||||||||||||
|
Для разделения фрагментов НК 150-750 п.н.. По четкости разделения фрагментов аналогичен ПААГ; гель с повышенной прозрачностью, ломкость минимизирована. Оптимальная концентрация 3 %.
Скачать: Агарозы MS4 и MS6, техническая инструкция, англ., 1 стр., 138 kB
См. таже: Какие факторы необходимо учитывать при выборе типа агарозы. Таблица выбора агарозы в зависимости от задачи исследования. Таблица выбора агарозы в зависимости от размеров целевых фрагментов.
|
|||||||||||||||||||||||||||||||||||||||||||
|
1951.0100
|
|||||||||||||||||||||||||||||||||||||||||||
|
Товар временно недоступен. Аналоги: арт. 911120.100 gm, 911120 .500 gm, CDH, Индия. Для разделения фрагментов НК более 1000 п.н.; для электрофореза НК , блоттинга, ДНК-фингерпринтирования. Не размывается, фрагменты при разделении четкие; нет различия по качеству между партиями.
Скачать:
|
|||||||||||||||||||||||||||||||||||||||||||
|
1952.0025
|
|||||||||||||||||||||||||||||||||||||||||||
|
Для разделения фрагментов НК и ПЦР продукта от 50 до 1000 п.н.; для аналитического и препаративного электрофореза НК; оптимальная концентрация 3-6%. Genetic Quality Tested – подходит для обработки агаразой, что позволяет легко восстанавливать небольшие фрагменты ДНК для клонирования и энзиматического расщепления; подходит для энзиматической обработки НК (лигирования, расщепления) в геле без предварительной экстракции.
См. также:
|
|||||||||||||||||||||||||||||||||||||||||||
|
|
|||||||||||||||||||||||||||||||||||||||||||
| Среды SOB (Super Optimal Broth) и SOC (Super Optimal broth with Catabolic repressor) богаты питательными веществами и применяются для выращивания компетентных клеток с последующей трансформацией; триптон обеспечивает азотом и углеродом, необходимыми для роста; дрожжевой экстракт является источником витаминов, в частности, группы В; ионы натрия и калия поддерживают необходимый осмос; сульфат магния является источником ионов магния, необходимых для работы бактериальных ферментов; глюкоза, входящая в состав среды SOC поставляет необходимый энергетический ресурс для восстановления клеток после трансформации и для репликации (в состав среды SOB глюкоза не входит), расход: среда SOB — 28 г на 1 л; среда SOC — 30 г на 1 л. |

|
|
Диаэм
Среда SOB |
|||||||||||||||||||||||||||
|
3132.0250
|
|
250 г
|
|
По запросу По запросу |
|
|
|
||||||||||||||||||||
|
|||||||||||||||||||||||||||
|
244310
|
|
500 г
|
|
64 670, руб.
|
|
|
|
||||||||||||||||||||
|
Используется для выращивания рекомбинантных штаммов E.coli. Пептон и дрожжевой экстракт, входящие в состав среды, обеспечивают азотом и ростовыми факторами, что помогает бактериям лучше перенести стресс после трансформации и расти лучше.
Внешний вид светло-бежевый сыпучий гомогенный материал
Растворимость растворим в дистиллированной воде
Внешний вид 2,8%-ного раствора средне-бежевый
pH при 25°C 7,0
Примерный состав среды, г/л:
Триптон, г/л 20
Дрожжевой экстракт, г/л 5
Хлорид натрия, г/л 0,5
Сульфат магния, г/л 2,4
Хлорид калия, г/л 0,186
Условия хранения в сухом месте при комнатной температуре
Скачать брошюры: Техническое руководство BD Bionutrients, 3-е издание, англ., 72 стр., 3 MB |
|||||||||||||||||||||||||||
|
Диаэм
Среда SOC |
|||||||||||||||||||||||||||
|
3133.0250
|
|||||||||||||||||||||||||||
|
|||||||||||||||||||||||||||
|
|
|||||||||||||||||||||||||||

|

|

|

|
|
Диаэм
Бульон LB по Lennox |
|||||||||||||||||||||||||
|
3134.0250
|
|||||||||||||||||||||||||
|
|||||||||||||||||||||||||
|
240230
|
|||||||||||||||||||||||||
|
Используется для поддержания и роста рекомбинантных штаммов E.coli в молекулярной биологии. Среда обогащена аминокислотами, нуклеотидами, витаминами и другими метаболитами, которые синтезируют микроорганизмы, это позволяет E.coli расти быстрее, чем на траиционных средах. Внешний вид светло-бежевый сыпучий гомогенный материал Растворимость растворим в дистиллированной воде Внешний вид 2,0%-ного раствора светло-янтарный, слегка опалесцирующий pH при 25° C 7,0 Примерный состав среды, г/л: Триптон, г/л 10 Дрожжевой экстракт, г/л 5 Хлорид натрия, г/л 5 Условия хранения в сухом месте при комнатной температуреСкачать брошюру: Состав сред для исследовательских задач микробиологии и молекулярной генетики, брошюра, англ., 7 стр., 508 kB |
|||||||||||||||||||||||||
|
3230
|
|
454 г
|
|
По запросу По запросу |
|
|
|
||||||||||||||||||
|
|||||||||||||||||||||||||
|
3135.0250
|
|||||||||||||||||||||||||
|
|||||||||||||||||||||||||
|
Диаэм
Агар LB по Lennox |
|||||||||||||||||||||||||
|
3139.0250
|
|||||||||||||||||||||||||
|
|||||||||||||||||||||||||
|
240110
|
|
500 г
|
|
РУ
Регистрационное удостоверение на медицинское изделие
Росздравнадзора
|
37 460, руб.
|
|
|
|
|||||||||||||||||
|
Используется для поддержания и роста рекомбинантных штаммов E.coli в молекулярной биологии. Среда обогащена аминокислотами, нуклеотидами, витаминами и другими метаболитами, которые синтезируют микроорганизмы, это позволяет E.coli расти быстрее, чем на традиционных средах. Внешний вид светло-бежевый сыпучий гомогенный материал Растворимость не растворяется в холодной воде, растворяется при кипячении в дистиллированной или деионизированной воде Внешний вид 3,5%-ного раствора средне-янтарный, слегка опалесцирующий pH при 25° C 7,0 Примерный состав среды, г/л: Триптон, г/л 10 Дрожжевой экстракт, г/л 5 Хлорид натрия, г/л 5 Агар, г/л 15 Условия хранения в сухом месте при комнатной температуреСкачать брошюру: Состав сред для исследовательских задач микробиологии и молекулярной генетики, брошюра, англ., 7 стр., 508 kB |
|||||||||||||||||||||||||
|
3136.0250
|
|||||||||||||||||||||||||
|
|||||||||||||||||||||||||
|
3137.0250
|
|||||||||||||||||||||||||
|
|||||||||||||||||||||||||
|
3138.0250
|
|||||||||||||||||||||||||
|
|||||||||||||||||||||||||
|
Диаэм
Агар LB по Miller |
|||||||||||||||||||||||||
|
3140.0250
|
|||||||||||||||||||||||||
|
|||||||||||||||||||||||||
|
244520
|
|||||||||||||||||||||||||
|
Используется для поддержания и роста рекомбинантных штаммов E.coli в молекулярной биологии. Среда обогащена аминокислотами, нуклеотидами, витаминами и другими метаболитами, которые синтезируют микроорганизмы, это позволяет E.coli расти быстрее, чем на традиционных средах. Внешний вид светло-бежевый сыпучий гомогенный материал Растворимость не растворяется в холодной воде, растворяется при кипячении в дистиллированной или деионизированной воде Внешний вид 4,0%-ного раствора средне-бежевый, слегка опалесцирующий pH при 25° C 7,0 Примерный состав среды, г/л: Триптон, г/л 10 Дрожжевой экстракт, г/л 5 Хлорид натрия, г/л 10 Агар, г/л 15 Условия хранения в сухом месте при комнатной температуреСкачать брошюру: Состав сред для исследовательских задач микробиологии и молекулярной генетики, брошюра, англ., 7 стр., 508 kB |
|||||||||||||||||||||||||
|
Диаэм
Бульон L по Miller |
|||||||||||||||||||||||||
|
3141.0250
|
|||||||||||||||||||||||||
|
|||||||||||||||||||||||||
|
244620
|
|||||||||||||||||||||||||
|
Используется для поддержания и роста рекомбинантных штаммов E.coli в молекулярной биологии. Среда обогащена аминокислотами, нуклеотидами, витаминами и другими метаболитами, которые синтезируют микроорганизмы, это позволяет E.coli расти быстрее, чем на традиционных средах. Внешний вид светло-бежевый сыпучий гомогенный материал Растворимость растворим в дистиллированной воде Внешний вид 2,5%-ного раствора средне-бежевый, слегка опалесцирующий pH при 25°C 7,0 Примерный состав среды, г/л: Триптон, г/л 10 Дрожжевой экстракт, г/л 5 Хлорид натрия, г/л 10 Условия хранения в сухом месте при комнатной температуре |
|||||||||||||||||||||||||
|
3142.0250
|
|||||||||||||||||||||||||
|
|||||||||||||||||||||||||
|
3143.0250
|
|||||||||||||||||||||||||
|
|||||||||||||||||||||||||
|
3144.0250
|
|||||||||||||||||||||||||
|
|||||||||||||||||||||||||
|
3145.0250
|
|||||||||||||||||||||||||
|
|||||||||||||||||||||||||
|
|
|||||||||||||||||||||||||
|
3146.0250
|
|||||||||||||||||||||||
|
|||||||||||||||||||||||
|
243820
|
|||||||||||||||||||||||
|
Сильно обогащенная среда, разработанная для увеличения роста штаммов E.coli, трансфецированных плазмидами. Пептон и дрожжевой экстракт, входящие в состав среды, позволяют получить больший выход плазмид. Внешний вид светло-бежевый сыпучий гомогенный материал Растворимость растворим в дистиллированной воде Внешний вид 4,76%-ного раствора светло-бежевый pH при 25°C 7,2 Примерный состав среды, г/л: Казеиновый пептон (расщепленный ферментами поджелудочной железы), г/л 12,0 Дрожжевой экстракт, г/л 24,0 Гидрофосфат калия, г/л 9,4 Дигидрофосфат калия, г/л 2,2 Условия хранения в сухом месте при комнатной температуреСкачать брошюры: Техническое руководство BD Bionutrients, 3-е издание, англ., 72 стр., 3 MB |
|||||||||||||||||||||||
|
3147.0250
|
|||||||||||||||||||||||
|
|||||||||||||||||||||||
|
|
|||||||||||||||||||||||
|
3148.0250
|
|||||||||||||||||||||||
|
|||||||||||||||||||||||
|
242720
|
|
500 г
|
|
По запросу По запросу |
|
|
|
||||||||||||||||
|
Используется для поддержания и размножения дрожжей; обогащена протеином и дрожжевым экстрактом, что обеспечивает более быстрый рост. Так, при экспоненциальном росте клетки делятся каждые 90 минут. Внешний вид светло-бежевый сыпучий гомогенный материал Растворимость не растворяется в холодной воде, растворяется при кипячении в дистиллированной или деионизированной воде Внешний вид 6,5%-ного раствора светло-бежевый, слегка опалесцирующий pH при 25°C 6,5 Примерный состав среды, г/л: Дрожжевой экстракт, г/л 10,0 Пептон, г/л 20,0 Декстроза, г/л 20,0 Агар, г/л 15,0 Условия хранения в сухом месте при комнатной температуреСкачать брошюру: Состав сред для исследовательских задач микробиологии и молекулярной генетики, брошюра, англ., 7 стр., 508 kB |
|||||||||||||||||||||||
|
242810
|
|
2 кг
|
|
По запросу По запросу |
|
|
|
||||||||||||||||
|
Используется для поддержания и размножения дрожжей; обогащена протеином и дрожжевым экстрактом, что обеспечивает более быстрый рост. Так, при экспоненциальном росте клетки делятся каждые 90 минут. Внешний вид светло-бежевый сыпучий гомогенный материал Растворимость растворим в дистиллированной воде Внешний вид 5,0%-ного раствора светло-бежевый, слегка опалесцирующий pH при 25°C 6,5 Примерный состав среды, г/л: Дрожжевой экстракт, г/л 10,0 Пептон, г/л 20,0 Декстроза, г/л 20,0 Агар, г/л 15,0 Условия хранения в сухом месте при комнатной температуреСкачать брошюру: Состав сред для исследовательских задач микробиологии и молекулярной генетики, брошюра, англ., 7 стр., 508 kB |
|||||||||||||||||||||||
|
|
|||||||||||||||||||||||
|
3149.0250
|
|||||||||||||||||||||||||
|
|||||||||||||||||||||||||
|
240410
|
|
500 г
|
|
По запросу По запросу |
|
|
|
||||||||||||||||||
|
Используется для выращивания рекомбинантных штаммов E.coli. Обогащенная среда NZCYM применяется для выращивания рекомбинантных штаммов E.coli и размножения фага λ. E.coli быстро растет на среде NZ, которая богата аминокислотами, витаминами и другими метаболитами. Внешний вид светло-бежевый сыпучий гомогенный материал Растворимость растворим в дистиллированной воде Внешний вид 2,2%-ного раствора светло-бежевый pH при 25°C 7,0 Примерный состав среды, г/л: Казеиновый пептон (расщепленный ферментами поджелудочной железы), г/л 10,0 Казаминовые кислоты, г/л 1,0 Дрожжевой экстракт, г/л 5,0 Хлорид натрия, г/л 5,0 Сульфат магния, г/л 0,98 Условия хранения в сухом месте при комнатной температуреСкачать брошюру: Состав сред для исследовательских задач микробиологии и молекулярной генетики, брошюра, англ., 7 стр., 508 kB |
|||||||||||||||||||||||||
|
|
|||||||||||||||||||||||||
|
244020
|
|
500 г
|
|
По запросу По запросу |
|
|
|
|||||
|
Разработана для роста рекомбинантных штаммов E.coli. Также используется для размножения фага М13. Компоненты среды богаты азотом и ростовыми факторами, что позволяет размножать фаг в больших количествах без истощения клетки-хозяина.
Внешний вид светло-бежевый сыпучий гомогенный материал
Растворимость растворим в дистиллированной воде
Внешний вид 3,1%-ного раствора средне-янтарный
pH при 25°C 7,0
Примерный состав среды, г/л:
Казеиновый пептон (расщепленный ферментами поджелудочной железы), г/л 16
Дрожжевой экстракт, г/л 10
Хлорид натрия, г/л 5
Условия хранения в сухом месте при комнатной температуре
Скачать брошюру: Состав сред для исследовательских задач микробиологии и молекулярной генетики, брошюра, англ., 7 стр., 508 kB |
||||||||||||
|
|
||||||||||||
|
3346.5000
|
|||||||||||||||||||||||||||||||||||||||
|
Агар изготавливается из нескольких видов красной водоросли, главным образом из Gelidium, Gracilaria и Pterocladia. Агар бактериологический европейский тип является желирующим агентом, применяемый в приготовлении микробиологических сред. Важной особенностью этого агара является отсутствие ингибиторов, которые могли бы повлиять на рост микроорганизмов. У агара бактериологического европейского типа отличная прозрачность и очень хорошая воспроизводимость. Каждая партия тестируется по биологическим показателям, чтобы обеспечить отсутствие ингибиторов и хороший рост микроорганизмов.
|
|||||||||||||||||||||||||||||||||||||||
|
3016.0500
|
|||||||||||||||||||||||||||||||||||||||
|
Производится из автолизата отборных штаммов дрожжей S. cerevisiae; дрожжевой экстракт служит источником азота свободных аминокислот, пептидов, витаминов и микроэлементов; используется в биотехнологическом производстве при производстве ферментов, гормонов, органических кислот, витаминов, антибиотиков, аминокислот и пептидов. Кроме этого данный пептон широко используется в пищевой промышленности при производстве заквасок, пробиотиков для здоровья человека и кормовживотных, выращивания грибов и макрофунгов, а также рекомендован при производстве культуральных сред и для диагностики.
|
|||||||||||||||||||||||||||||||||||||||
|
3017.0500
|
|||||||||||||||||||||||||||||||||||||||
|
Производится из автолизата отборных штаммов дрожжей S. cerevisiae; ультрафильтрованный дрожжевой экстракт служит источником азота свободных аминокислот, пептидов, витаминов и микроэлементов; рекомендован при производстве культуральных сред и для диагностики. Данный экстракт полностью растворим, имеет высокий уровень азота, богат пептидами.
|
|||||||||||||||||||||||||||||||||||||||
|
3014.20000
|
|
20 кг
|
|
По запросу По запросу |
|
|
|
||||||||||||||||||||||||||||||||
|
Получен ферментативным гидролизом дрожжевых белков из отборных штаммов S cerevisiae; пептон дрожжевой служит источником азота свободных аминокислот, пептидов, витаминов, и микроэлементов; используется в качестве замены белков животного или растительного происхождения; применяется для приготовления питательных сред, в пищевой промышленности, при производстве пробиотиков, биопрепаратов, ферментов и других био-продуктов.
|
|||||||||||||||||||||||||||||||||||||||
|
3338.5000
|
|||||||||||||||||||||||||||||||||||||||
|
Пептон мясной бактериологический является панкреатическим гидролизатом животных тканей, обогащенный факторами роста, предназначенные для применения в диагностике.
|
|||||||||||||||||||||||||||||||||||||||
|
|
|||||||||||||||||||||||||||||||||||||||
|
Диаэм
Альбумин бычий сывороточный, CAS 9048-46-8, не менее 99% |
|||||||||||||||||||||||||||||||||||||||||||||||||||||||
|
BSA.0100
|
|
100 г
|
транспортировка +2...+8 °C
|
|
6 067, руб.
|
|
|
|
|||||||||||||||||||||||||||||||||||||||||||||||
|
Синоним(ы): Albumin bovine serum, BSA, Bovine albumin, Albumin, Bovine Serum, Bovine Serum Albumin, Бычий сывороточный альбумин, БСА, бычий альбумин, альбумин, бычья сыворотка.
|
|||||||||||||||||||||||||||||||||||||||||||||||||||||||
|
3356.0025
|
|||||||||||||||||||||||||||||||||||||||||||||||||||||||
|
Синоним(ы): 2,2-Бис(гидроксиметил)-2,2′,2″-нитрилотриэтанол, 2-Бис(2-гидроксиэтил)амино-2-(гидроксиметил)-1,3-пропандиол, Бис(2-гидроксиэтил)амино-трис(гидроксиметил)метан, BIS-TRIS, 2,2-Bis(hydroxymethyl)-2,2′,2″-nitrilotriethanol, 2-Bis(2-hydroxyethyl)amino-2-(hydroxymethyl)-1,3-propanediol, Bis(2-hydroxyethyl)amino-tris(hydroxymethyl)methane.
|
|||||||||||||||||||||||||||||||||||||||||||||||||||||||
|
Диаэм
Гуанидин гидрохлорид, CAS 50-01-1, не менее 98% |
|||||||||||||||||||||||||||||||||||||||||||||||||||||||
|
10005172.0100
|
|||||||||||||||||||||||||||||||||||||||||||||||||||||||
|
Синонимы: аминометанамид гидрохлорид, аминоформамид гидрохлорид, хлорид гуанидиния, гуанидин солянокислый, карбамидин гидрохлорид, Aminoformamidine hydrochloride, Aminomethanamidine hydrochloride, Guanidinium chloride, Guanidine hydrochloride, Carbamidine hydrochloride.
|
|||||||||||||||||||||||||||||||||||||||||||||||||||||||
|
Импорт
Гуанидин гидрохлорид, CAS 50-01-1, не менее 99,5%, Biopharmaceutical grade, ultrapure |
|||||||||||||||||||||||||||||||||||||||||||||||||||||||
|
140000279.0100
|
|||||||||||||||||||||||||||||||||||||||||||||||||||||||
|
Гуанидин гидрохлорид Biopharmaceutical grade (ultrapure) используется в биофармацевтическом производстве (например, для выделения и экстракции моноклональных антител или рекомбинантных белков) , для диагностики ( например, в экстракционных буферах для выделения нуклеиновых кислот из биологических образцов, в тест-набора для вирусная РНК / ДНК)
Синонимы: аминометанамид гидрохлорид, аминоформамид гидрохлорид, хлорид гуанидиния, гуанидин солянокислый, карбамидин гидрохлорид, Aminoformamidine hydrochloride, Aminomethanamidine hydrochloride, Guanidinium chloride, Guanidine hydrochloride, Carbamidine hydrochloride.
|
|||||||||||||||||||||||||||||||||||||||||||||||||||||||
|
Импорт
Гуанидин гидрохлорид, CAS 50-01-1, не менее 99,7%, Molecular biology grade, ultrapure |
|||||||||||||||||||||||||||||||||||||||||||||||||||||||
|
140000295.0100
|
|||||||||||||||||||||||||||||||||||||||||||||||||||||||
|
Гуанидин гидрохлорид используется Molecular biology grade, ultrapure в биофармацевтическом производстве (например, для выделения и экстракции моноклональных антител или рекомбинантных белков) , для диагностики ( например, в экстракционных буферах для выделения нуклеиновых кислот из биологических образцов, в тест-набора для вирусная РНК / ДНК)
Синонимы: аминометанамид гидрохлорид, аминоформамид гидрохлорид, хлорид гуанидиния, гуанидин солянокислый, карбамидин гидрохлорид, Aminoformamidine hydrochloride, Aminomethanamidine hydrochloride, Guanidinium chloride, Guanidine hydrochloride, Carbamidine hydrochloride.
|
|||||||||||||||||||||||||||||||||||||||||||||||||||||||
|
Импорт
Гуанидин тиоционат, CAS 593-84-0, не менее 98,5%, pure |
|||||||||||||||||||||||||||||||||||||||||||||||||||||||
|
140001080.0100
|
|
100 г
|
|
По запросу По запросу |
|
|
|
||||||||||||||||||||||||||||||||||||||||||||||||
|
Гуанидин тиоционат (pur.) - вспомогательный реагент для выделения и выделения РНК / ДНК. Используется для тест-наборов для (вирусной) РНК / ДНК в клинической диагностике, а также для подготовки образцов для диагностики на основе ПЦР.
CAS-No. 593-84-0
Химическая формула – C2H6N4S Молярный вес – 118,16 г/моль Содержание основного вещества (титр.) – не менее 98,5% Растворимость – 3 М (H2O) Внешний вид бесцветные кристаллы Точка плавления 117 – 121 ºС рН (1 М) 5,0 – 7,0 Содержание воды – не более 0,3% Аммоний – не более 0,1% Сульфаты – не более 0,1 % Железо – не более 1 мг/кг Условия хранения: в сухом и прохладном месте
|
|||||||||||||||||||||||||||||||||||||||||||||||||||||||
|
Импорт
Гуанидин тиоцианат, CAS 593-84-0, не менее 99%, ultrapure |
|||||||||||||||||||||||||||||||||||||||||||||||||||||||
|
140000274.0100
|
|||||||||||||||||||||||||||||||||||||||||||||||||||||||
|
Гуанидин тиоцианат (ultrapure) – вспомогательный реагент для выделения и выделения РНК / ДНК. Используется для тест-наборов для (вирусной) РНК / ДНК в клинической диагностике, а также для подготовки образцов для диагностики на основе ПЦР.
|
|||||||||||||||||||||||||||||||||||||||||||||||||||||||
|
Импорт
Дитиотреитол-DL, не менее 100% |
|||||||||||||||||||||||||||||||||||||||||||||||||||||||
|
D3483123.0005
|
|
5 г
|
хранение +2...+8 в темноте, транспортировка +2...+8 в темноте
|
|
По запросу По запросу |
|
|
|
|||||||||||||||||||||||||||||||||||||||||||||||
|
Синоним: DTT, реагент Клеланда
|
|||||||||||||||||||||||||||||||||||||||||||||||||||||||
|
R0392
|
|
5 г
|
транспортировка +4°C
|
|
33 700, руб.
33 700, руб. RUB
|
|
|
|
|||||||||||||||||||||||||||||||||||||||||||||||
|
ИПТГ (Изопропил-β-D-1-тиогалактопиранозид) - высокостабильный аналог лактозы. Он инактивирует lac-репрессор и индуцирует синтез бета-галактозидазы, фермента, метаболизирующего лактозу. Используется как индуктор экспрессии генов, клонированных под контроль lac-оперона. Также используется совместно с X-Gal для бело-голубой селекции клонов. Рекомендуется приготовление стокового раствора в концентрации 100 мМ. Для бело-голубой селекции используется конечная концентрация 0.1 мМ. Условия хранения: +4оС
|
|||||||||||||||||||||||||||||||||||||||||||||||||||||||
|
Импорт
Метилен-бис-акриламид, чда, 99%, CAS 110-26-9, более 99,3%, чда |
|||||||||||||||||||||||||||||||||||||||||||||||||||||||
|
U110269.0050
|
|
50 г
|
хранение +2...+8°C, транспортировка +2...+8 °C
|
|
1 448, руб.
|
|
|
|
|||||||||||||||||||||||||||||||||||||||||||||||
|
|||||||||||||||||||||||||||||||||||||||||||||||||||||||
|
3352.0100
|
|||||||||||||||||||||||||||||||||||||||||||||||||||||||
|
|||||||||||||||||||||||||||||||||||||||||||||||||||||||
|
Диаэм
Трис(гидроксиметил)аминометан, CAS 77-86-1, 99% |
|||||||||||||||||||||||||||||||||||||||||||||||||||||||
|
3353.0100
|
|||||||||||||||||||||||||||||||||||||||||||||||||||||||
|
|||||||||||||||||||||||||||||||||||||||||||||||||||||||
|
DE108952.0100
|
|
100 г
|
|
802, руб.
802, руб. RUB
|
|
|
|
||||||||||||||||||||||||||||||||||||||||||||||||
|
|||||||||||||||||||||||||||||||||||||||||||||||||||||||
|
R0404
|
|
1 г
|
транспортировка -20°C
|
|
40 600, руб.
40 600, руб. RUB
|
|
|
|
|||||||||||||||||||||||||||||||||||||||||||||||
|
X-gal, или 5-бром-4-хлор-3-индолил-бета-D-галактопиранозид — хромогенный субстрат для фермента бета-галактозидазы. При расщеплении бета-галактозидазой от субстрата отщепляется индольная структура, которая спонтанно окисляется и выпадает в виде осадка синего цвета. Это свойство широко используется в молекулярной и клеточной биологии.
В первую очередь, X-gal применяется для анализа активности репортерного гена lacZ, кодирующего бета-галактозидазу, в клетках бактерий, дрожжей и животных. В растениях в качестве репортерного гена, маркером активности которого также является X-gal, используется ген GUS. Также X-gal используется совместно с конъюгатами гликозидаз в качестве реагента для вторичной детекции при иммуногистохимии и ELISA.Наконец, поскольку бета-галактозидаза сохраняет свою активность в фиксированных клетках и тканях, X-gal используется для детекции её активности.
|
|||||||||||||||||||||||||||||||||||||||||||||||||||||||
|
PanReac Applichem
Этидиум бромид, 1% раствор, BioChemica |
|||||||||||||||||||||||||||||||||||||||||||||||||||||||
|
A-1152,0025
|
|
25 мл
|
транспортировка -8...+2°C
|
|
По запросу По запросу |
|
|
|
|||||||||||||||||||||||||||||||||||||||||||||||
|
Товар временно недоступен. Аналоги по запросу ниже.
|
|||||||||||||||||||||||||||||||||||||||||||||||||||||||
|
|
|||||||||||||||||||||||||||||||||||||||||||||||||||||||
С помощью личного кабинета Вы сможете:
Сравнение